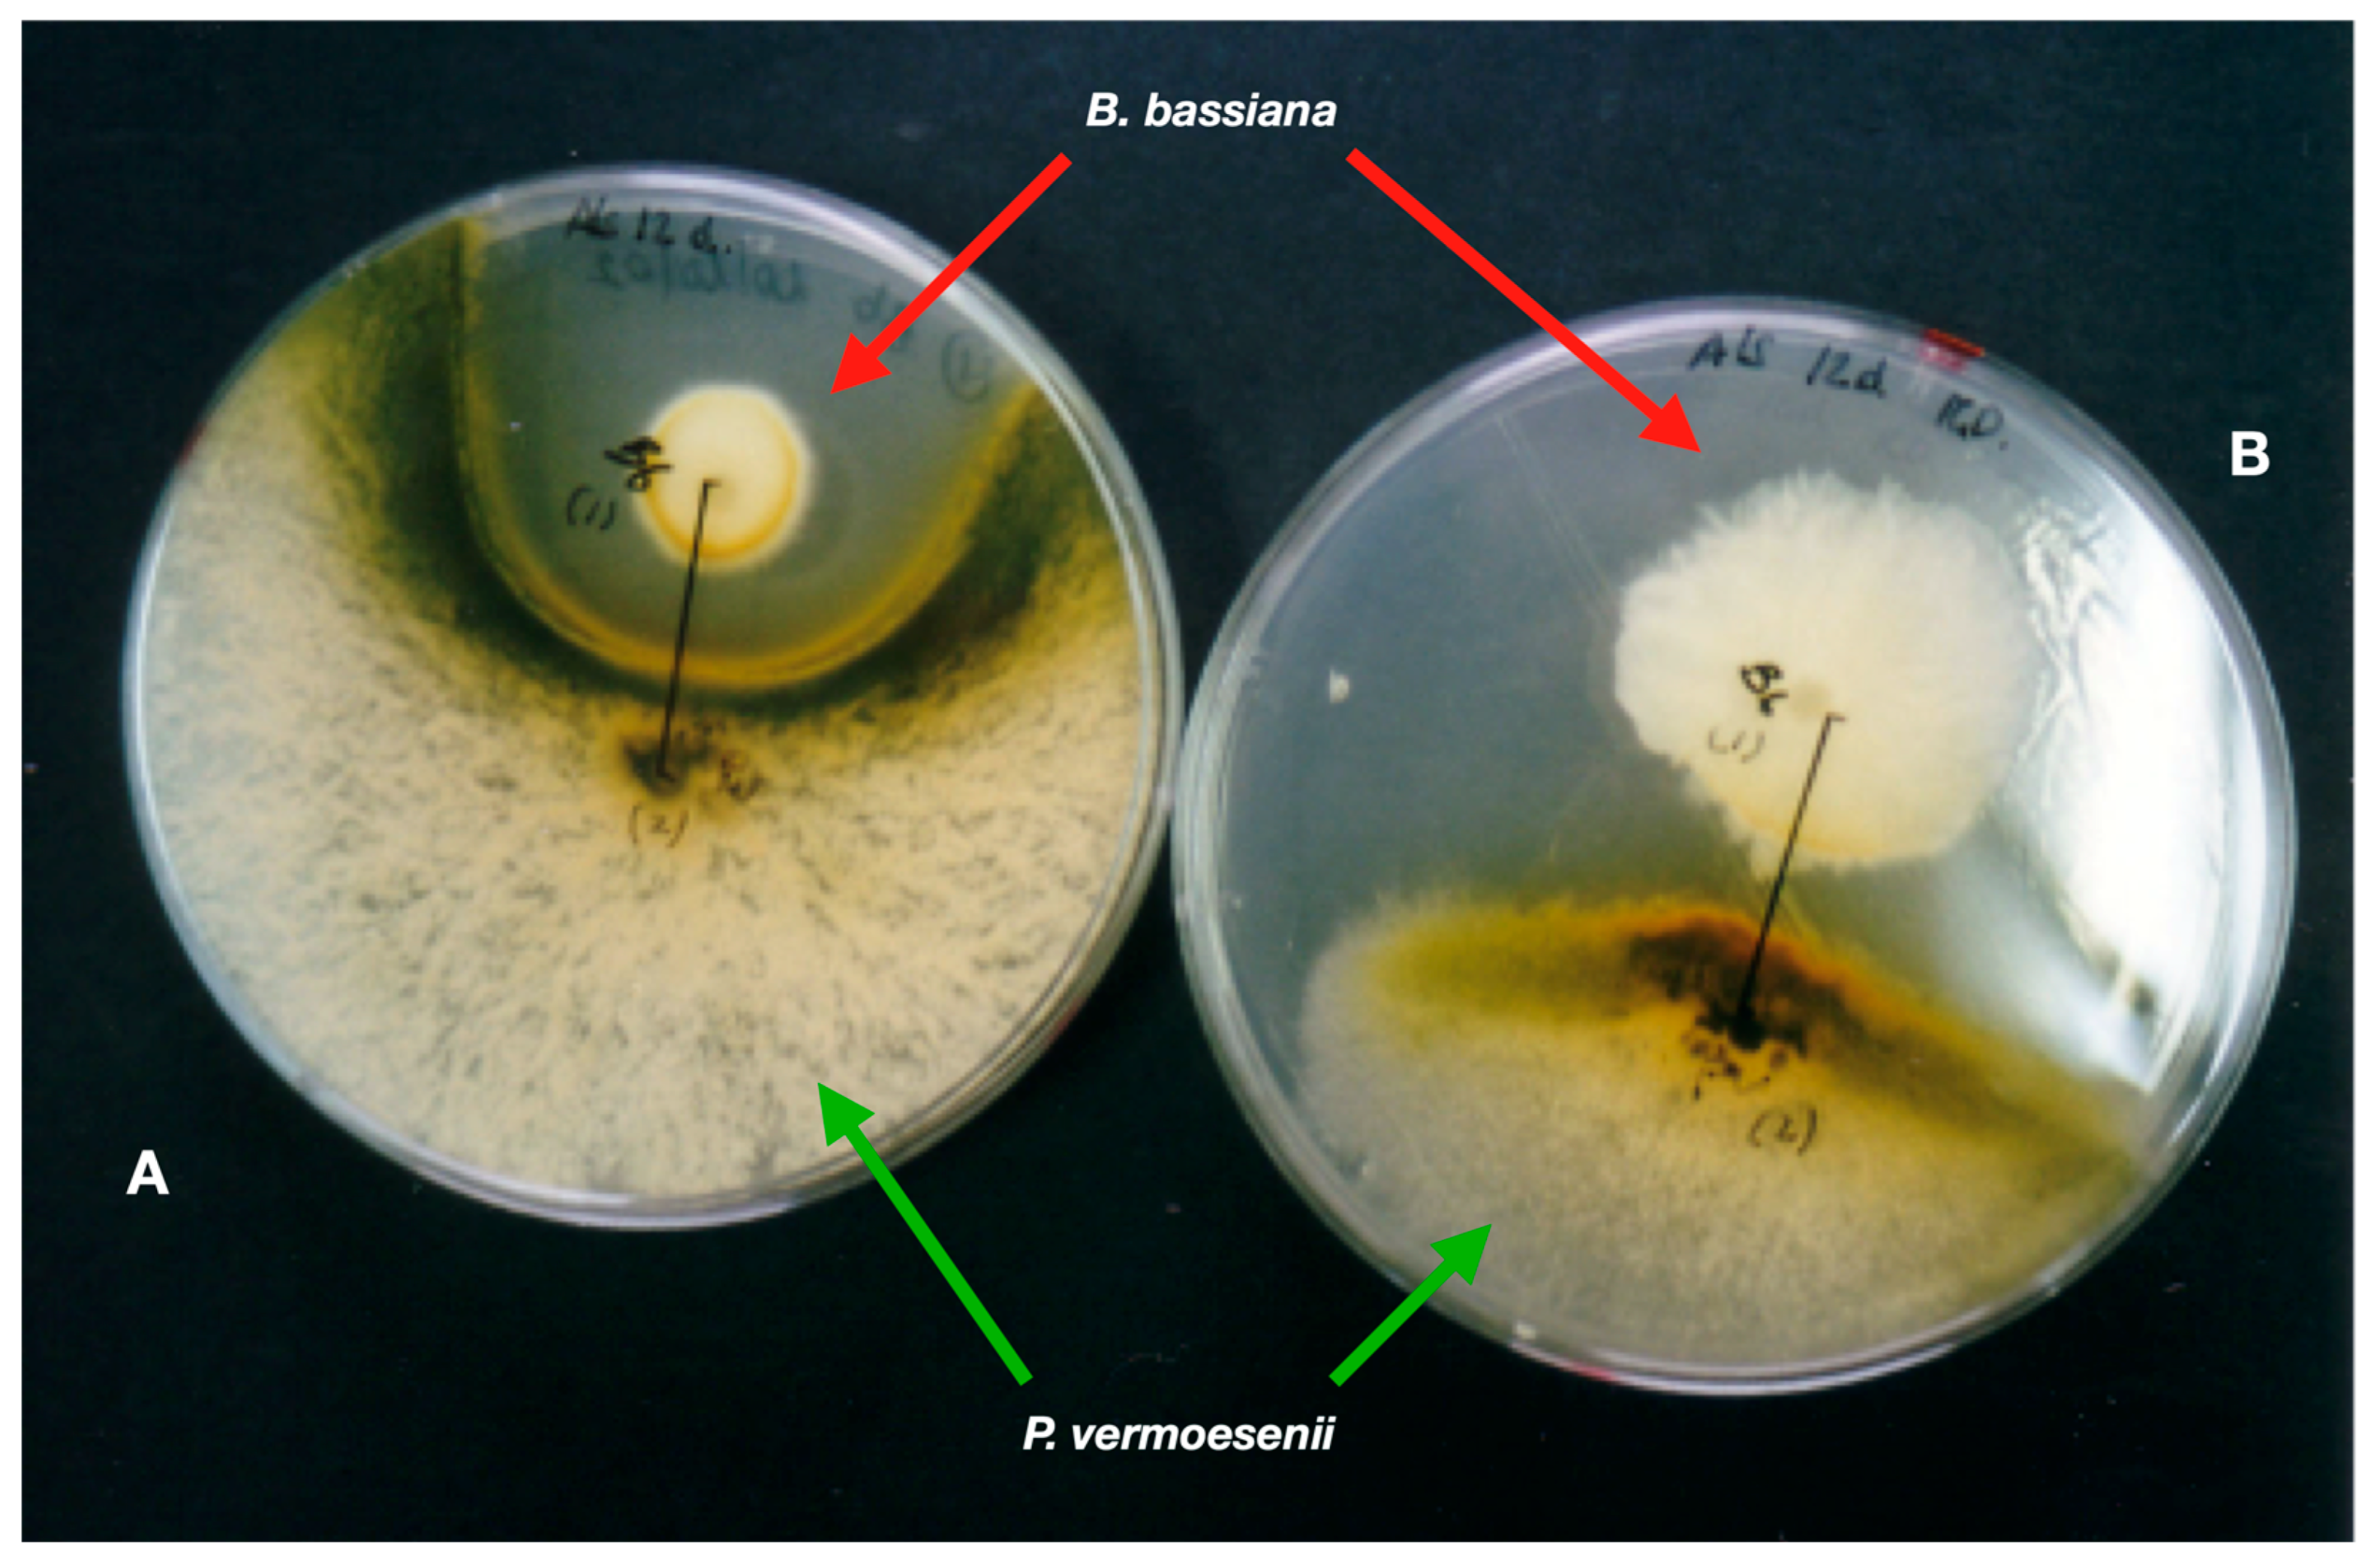
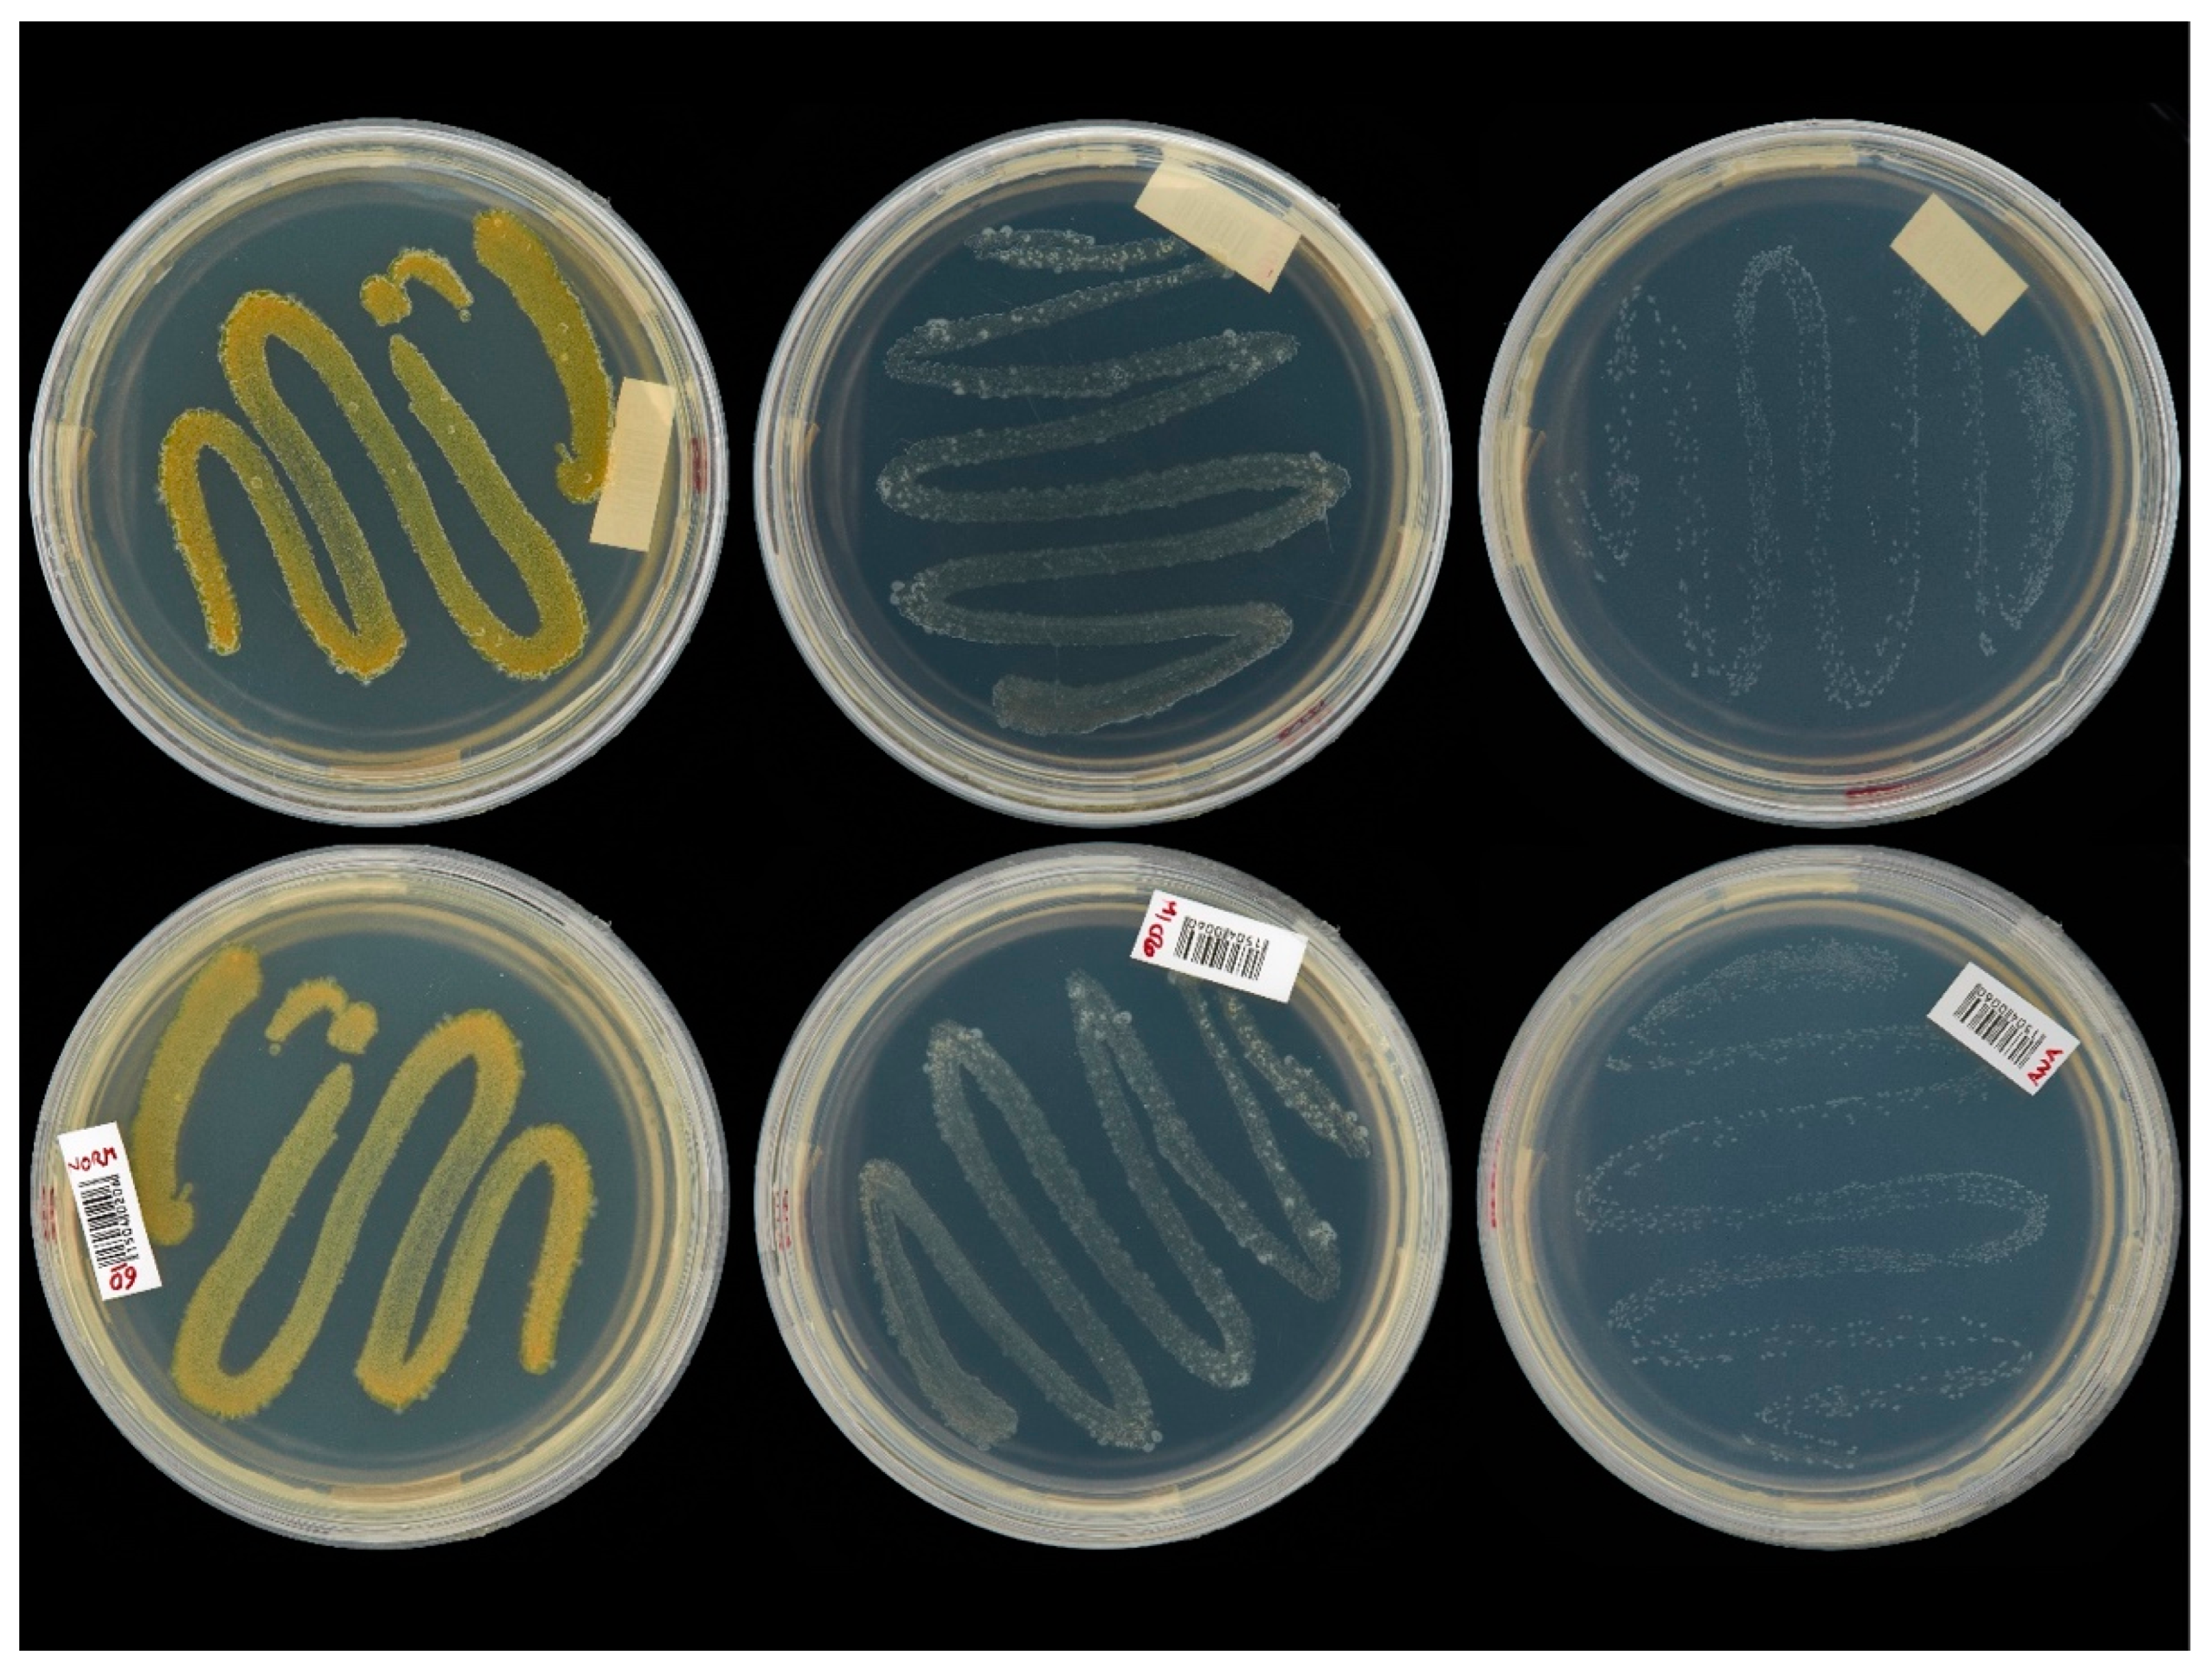

“Ectomosphere”: Insects and Microorganism Interactions
Abstract
1. Introduction
2. Endosymbiotic Bacteria in Pests
3. Pathogens Spread by Monophagous Vectors: Candidatus Phytoplasma Vitis
4. Genomic Clues in Insect Pathogenic Viruses
5. Interactions between Entomopathogenic Fungi and Pests
6. Multitrophic Interactions of Entomopathogenic Fungi, Crops, and Insects
7. Native Entomopathogenic Fungi Used for Microbial Control of the Rhynchophorus palmarum (L., 1758)
8. Bactrocera oleae, Colletotrichum spp. Ectosymbionts and Olive Anthracnose in Mediterranean Areas
9. Grape Berry Moth (Lobesia botrana) Interaction with Botrytis cinerea and Ochratoxigenic Aspergillus Species
10. Pathogens Spread by Polyphagous Vectors: Xylella fastidiosa
11. Detection of Xylella fastidiosa subsp. pauca from the Insect Vector
12. Bacteria Symbionts of Red Palm Weevil
13. Aphrophoridae Froth Niche
14. Aureobasidium spp.: Multitasking Beneficial Microorganism
15. Conclusions
Author Contributions
Funding
Data Availability Statement
Conflicts of Interest
Abbreviations
References
- Basset, Y.; Cizek, L.; Cuénoud, P.; Didham, R.K.; Guilhaumon, F.; Missa, O.; Novotny, V.; Ødegaard, F.; Roslin, T.; Schmidl, J.; et al. Arthropod diversity in a tropical forest. Science 2012, 338, 1481–1484. [Google Scholar] [CrossRef]
- Engel, M.S. Insect evolution. Curr. Biol. 2015, 25, R868–R872. [Google Scholar] [CrossRef] [PubMed]
- Berenbaum, M. Insect biodiversity—Millions and millions. In Insect Biodiversity; Foottit, R.G., Adler, P.H., Eds.; John Wiley & Sons, Ltd.: Chichester, UK, 2017; pp. 783–792. [Google Scholar]
- Tihelka, E.; Cai, C.; Giacomelli, M.; Lozano-Fernandez, J.; Rota-Stabelli, O.; Huang, D.; Engel, M.S.; Donoghue, P.C.J.; Pisani, D. The evolution of insect biodiversity. Curr. Biol. 2021, 31, R1299–R1311. [Google Scholar] [CrossRef] [PubMed]
- de Bary, H.A. Die Erscheinung der Symbiose: Vortrag, Gehalten auf der Versammlung Deutscher Naturforscher und Aerzte zu Cassel; Verlag von Karl J. Trübner: Strassburg, Germany, 1879. [Google Scholar]
- Tellez, G. Prokaryotes versus eukaryotes: Who is hosting whom? Front. Vet. Sci. 2014, 1, 3. [Google Scholar] [CrossRef]
- Hosokawa, T.; Fukatsu, T. Relevance of microbial symbiosis to insect behavior. Curr. Opin. Insect Sci. 2020, 39, 91–100. [Google Scholar] [CrossRef] [PubMed]
- Douglas, A.E. Mycetocyte symbiosis in insects. Biol. Rev. 1989, 64, 409–434. [Google Scholar] [CrossRef]
- Moya, A.; Peretó, J.; Gil, R.; Latorre, A. Learning how to live together: Genomic insights into prokaryote–animal symbioses. Nat. Rev. Genet. 2008, 9, 218–229. [Google Scholar] [CrossRef] [PubMed]
- Engel, P.; Moran, N.A. The gut microbiota of insects—Diversity in structure and function. FEMS Microbiol. Rev. 2013, 37, 699–735. [Google Scholar] [CrossRef] [PubMed]
- Ferrari, J.; Vavre, F. Bacterial symbionts in insects or the story of communities affecting communities. Philos. Trans. R. Soc. B Biol. Sci. 2011, 366, 1389–1400. [Google Scholar] [CrossRef]
- Frago, E.; Dicke, M.; Godfray, H.C.J. Insect symbionts as hidden players in insect–plant interactions. Trends Ecol. Evol. 2012, 27, 705–711. [Google Scholar] [CrossRef]
- Leung, T.L.F.; Poulin, R. Parasitism, commensalism, and mutualism: Exploring the many shades of symbioses. Vie Milieu 2008, 58, 107–115. [Google Scholar]
- Baverstock, J.; Roy, H.E.; Pell, J.K. Entomopathogenic fungi and insect behaviour: From unsuspecting hosts to targeted vectors. BioControl 2010, 55, 89–102. [Google Scholar] [CrossRef]
- Roy, H.E.; Steinkraus, D.C.; Eilenberg, J.; Hajek, A.E.; Pell, J.K. Bizarre interactions and endgames: Entomopathogenic fungi and their arthropod hosts. Annu. Rev. Entomol. 2006, 51, 331–357. [Google Scholar] [CrossRef] [PubMed]
- Molfetta, M.; Morais, E.G.; Barreira, L.; Bruno, G.L.; Porcelli, F.; Dugat-Bony, E.; Bonnarme, P.; Minervini, F. Protein sources alternative to meat: State of the art and involvement of fermentation. Foods 2022, 11, 2065. [Google Scholar] [CrossRef] [PubMed]
- Dillon, R.J.; Dillon, V.M. The gut bacteria of insects: Nonpathogenic interactions. Annu. Rev. Entomol. 2004, 49, 71–92. [Google Scholar] [CrossRef]
- Steinhaus, E.A. The microbiology of insect with special reference to the biologic relastionships between bacteria and insects. Bacteriol. Rev. 1940, 4, 17–57. [Google Scholar] [CrossRef] [PubMed]
- Peglion, V. Le Malattie Crittogamiche Delle Piante Coltivate, 3rd ed.; Biblioteca Agraria Ottavi; Stab. Tip. Ditta C. Cassone: Casale Monferrato, Italy, 1912; Volume 21, p. 554. [Google Scholar]
- Tonelli, A. Una bacteriosi del Leandro (Rogna, o Cancro, o Tubercolosi del Leandro). Ann. R. Accad. Agric. Torino 1913, LV, 383–400. [Google Scholar]
- Landmann, F. The Wolbachia endosymbionts. Microbiol. Spectr. 2019, 7, 15. [Google Scholar] [CrossRef]
- Sazama, E.J.; Ouellette, S.P.; Wesner, J.S. Bacterial endosymbionts are common among, but not necessarily within, insect species. Environ. Entomol. 2019, 48, 127–133. [Google Scholar] [CrossRef]
- Scrascia, M.; Pazzani, C.; Valentini, F.; Oliva, M.; Russo, V.; D’Addabbo, P.; Porcelli, F. Identification of pigmented Serratia marcescens symbiotically associated with Rhynchophorus ferrugineus Olivier (Coleoptera: Curculionidae). MicrobiologyOpen 2016, 5, 883–890. [Google Scholar] [CrossRef]
- Scrascia, M.; D’Addabbo, P.; Roberto, R.; Porcelli, F.; Oliva, M.; Calia, C.; Dionisi, A.M.; Pazzani, C. Characterization of CRISPR-Cas systems in Serratia marcescens isolated from Rhynchophorus ferrugineus (Olivier, 1790) (Coleoptera: Curculionidae). Microorganisms 2019, 7, 368. [Google Scholar] [CrossRef] [PubMed]
- EPPO Activities on Plant Quarantine 2022. Available online: https://www.eppo.int/ACTIVITIES/quarantine_activities (accessed on 30 January 2023).
- Perilla-Henao, L.M.; Casteel, C.L. Vector-borne bacterial plant pathogens: Interactions with hemipteran insects and plants. Front. Plant Sci. 2016, 7, 1163. [Google Scholar] [CrossRef] [PubMed]
- Bertin, S.; Guglielmino, C.R.; Karam, N.; Gomulski, L.M.; Malacrida, A.R.; Gasperi, G. Diffusion of the Nearctic leafhopper Scaphoideus titanus Ball in Europe: A consequence of human trading activity. Genetica 2007, 131, 275–285. [Google Scholar] [CrossRef] [PubMed]
- EFSA Panel on Plant Health (PLH); Bragard, C.; Dehnen-Schmutz, K.; Di Serio, F.; Gonthier, P.; Jacques, M.; Jaques Miret, J.A.; Justesen, A.F.; Magnusson, C.S.; Milonas, P.; et al. Pest categorisation of non-EU Cicadomorpha vectors of Xylella spp. EFSA J. 2019, 17, e05765. [Google Scholar] [PubMed]
- Chuche, J.; Thiéry, D. Biology and ecology of the Flavescence Dorée vector Scaphoideus titanus: A review. Agron. Sustain. Dev. 2014, 34, 381–403. [Google Scholar] [CrossRef]
- Belli, G.; Bianco, P.A.; Conti, M. Grapevine Yellows in Italy: Past, present and future. J. Plant Pathol. 2010, 92, 303–326. [Google Scholar]
- Pearson, R.C.; Pool, R.M.; Gonsalves, D.; Goffinet, M.C. Occurrence of Flavescence Dorée-like symptoms on “White Riesling” grapevines in New York, U.S.A. Phytopathol. Mediterr. 1985, 24, 82–87. [Google Scholar]
- Boudon-Padieu, E. The situation of Grapevine Yellows and current research directions: Distribution, diversity, vectors, diffusion and control. In Proceedings of the 14th ICVG Conference, Locorotondo, Italy, 17 September 2003. [Google Scholar]
- Morone, C.; Boveri, M.; Giosuè, S.; Gotta, P.; Rossi, V.; Scapin, I.; Marzachì, C. Epidemiology of Flavescence Dorée in vineyards in northwestern Italy. Phytopathology 2007, 97, 1422–1427. [Google Scholar] [CrossRef]
- Falzoi, S.; Lessio, F.; Spanna, F.; Alma, A. Influence of temperature on the embryonic and post-embryonic development of Scaphoideus titanus (Hemiptera: Cicadellidae), vector of grapevine Flavescence Dorée. Int. J. Pest Manag. 2014, 60, 246–257. [Google Scholar] [CrossRef]
- Caudwell, A.; Kuszla, C.; Larrue, J.; Bachelier, J.C. Transmission de la Flavescence Dorée de la feve a la feve par des cicadelles des genres Euscelis et Euscelidius: Intervention possible de ces insectes dans l’epidemiologie du bois noir en Bourgogne. Ann. Phytopathol. 1972, 1572, 181–189. [Google Scholar]
- Boudon-Padieu, E. Grapevine phytoplasmas. In Proceedings of the 1st Internet Conference on Phytopathogenic Mollicutes, Udine, Italy, 24–29 May 1999. [Google Scholar]
- Bonfils, J.; Schvester, D. The leafhoppers (Homoptera: Auchenorrhyncha) and their relationship with vineyards in south-western France. Ann. Epiphyt. 1960, 11, 325–336. [Google Scholar]
- Vidano, C. Scoperta in Italia dello Scaphoideus littoralis Ball cicalina americana collegata alla Flavescence Dorée della vite. Ital. Agric. 1964, 101, 1031–1049. [Google Scholar]
- Maggi, F.; Galetto, L.; Marzachì, C.; Bosco, D. Temperature-dependent transmission of Candidatus Phytoplasma asteris by the vector leafhopper Macrosteles quadripunctulatus Kirschbaum. Entomologia 2014, 2, 87–94. [Google Scholar] [CrossRef]
- Alma, A.; Lessio, F.; Gonella, E.; Picciau, L.; Mandrioli, M.; Tota, f. Acquisition and inoculation of FD phytoplasmas by adults of Scaphoideus titanus Ball: Less time is required. In Proceedings of the XI European Congress of Entomology, Napoli, Italy, 6 July 2018. [Google Scholar]
- Ripamonti, M.; Maron, F.; Cornara, D.; Marzachì, C.; Fereres, A.; Bosco, D. Leafhopper feeding behaviour on three grapevine cultivars with different susceptibilities to Flavescence Dorée. J. Insect Physiol. 2022, 137, 104366. [Google Scholar] [CrossRef]
- Bressan, A.; Girolami, V.; Boudon-Padieu, E. Reduced fitness of the leafhopper vector Scaphoideus titanus exposed to Flavescence Dorée phytoplasma. Entomol. Exp. Appl. 2005, 115, 283–290. [Google Scholar] [CrossRef]
- Arricau-Bouvery, N.; Duret, S.; Dubrana, M.-P.; Desqué, D.; Eveillard, S.; Brocard, L.; Malembic-Maher, S.; Foissac, X. Interactions between the Flavescence Dorée phytoplasma and its insect vector indicate lectin-type adhesion mediated by the adhesin VmpA. Sci. Rep. 2021, 11, 11222. [Google Scholar] [CrossRef]
- Ministero Delle Politiche Agricole e Forestali. Decreto Ministeriale No. 32442 del 31 Maggio 2000. Available online: https://www.regione.veneto.it/static/www/agricoltura-e-foreste/dm_31_05_00.pdf (accessed on 1 September 2022).
- Pavan, F.; Mori, N.; Bigot, G.; Zandigiacomo, P. Border effect in spatial distribution of Flavescence Dorée affected grapevines and outside source of Scaphoideus titanus vectors. Bull. Insectology 2012, 65, 281–290. [Google Scholar]
- Consorzio Fitosanitario Provinciale di Reggio Emilia. Available online: https://www.fitosanitario.re.it (accessed on 30 January 2023).
- Wu, H.; Pang, R.; Cheng, T.; Xue, L.; Zeng, H.; Lei, T.; Chen, M.; Wu, S.; Ding, Y.; Zhang, J.; et al. Abundant and diverse RNA viruses in insects revealed by RNA-seq analysis: Ecological and evolutionary implications. mSystems 2020, 5, e00039-20. [Google Scholar] [CrossRef] [PubMed]
- Käfer, S.; Paraskevopoulou, S.; Zirkel, F.; Wieseke, N.; Donath, A.; Petersen, M.; Jones, T.C.; Liu, S.; Zhou, X.; Middendorf, M.; et al. Re-assessing the diversity of negative strand RNA viruses in insects. PLoS Pathog. 2019, 15, e1008224. [Google Scholar] [CrossRef]
- Abd-Alla, A.M.M.; Meki, I.K.; Demirbas-Uzel, G. Insect viruses as biocontrol agents: Challenges and opportunities. In Cottage Industry of Biocontrol Agents and Their Applications; El-Wakeil, N., Saleh, M., Abu-hashim, M., Eds.; Springer International Publishing: Cham, Switzerland, 2020; pp. 277–295. [Google Scholar]
- Beas-Catena, A.; Sánchez-Mirón, A.; García-Camacho, F.; Contreras-Gómez, A.; Molina-Grima, E. Baculovirus biopesticides: An overview. J. Anim. Plant Sci. 2014, 24, 362–373. [Google Scholar]
- Beperet, I.; Simón, O.; López-Ferber, M.; van Lent, J.; Williams, T.; Caballero, P. Mixtures of insect-pathogenic viruses in a single virion: Towards the development of custom-designed insecticides. Appl. Environ. Microbiol. 2021, 87, e02180-20. [Google Scholar] [CrossRef] [PubMed]
- Boughton, A.J.; Obrycki, J.J.; Bonning, B.C. Effects of a protease-expressing recombinant baculovirus on nontarget insect predators of Heliothis virescens. Biol. Control 2003, 28, 101–110. [Google Scholar] [CrossRef]
- Cheng, R.-L.; Xi, Y.; Lou, Y.-H.; Wang, Z.; Xu, J.-Y.; Xu, H.-J.; Zhang, C.-X. Brown planthopper nudivirus DNA integrated in its host genome. J. Virol. 2014, 88, 5310–5318. [Google Scholar] [CrossRef]
- Irwin, N.A.T.; Pittis, A.A.; Richards, T.A.; Keeling, P.J. Systematic evaluation of horizontal gene transfer between eukaryotes and viruses. Nat. Microbiol. 2022, 7, 327–336. [Google Scholar] [CrossRef]
- Bézier, A.; Annaheim, M.; Herbinière, J.; Wetterwald, C.; Gyapay, G.; Bernard-Samain, S.; Wincker, P.; Roditi, I.; Heller, M.; Belghazi, M.; et al. Polydnaviruses of braconid wasps derive from an ancestral nudivirus. Science 2009, 323, 926–930. [Google Scholar] [CrossRef] [PubMed]
- Wang, Y.; Burand, J.P.; Jehle, J.A. Nudivirus genomics: Diversity and classification. Virol. Sin. 2007, 22, 128–136. [Google Scholar] [CrossRef]
- Wang, Y.; Kleespies, R.G.; Huger, A.M.; Jehle, J.A. The genome of Gryllus bimaculatus nudivirus indicates an ancient diversification of baculovirus-related nonoccluded nudiviruses of insects. J. Virol. 2007, 81, 5395–5406. [Google Scholar] [CrossRef]
- Cheng, R.-L.; Li, X.-F.; Zhang, C.-X. Nudivirus remnants in the genomes of arthropods. Genome Biol. Evol. 2020, 12, 578–588. [Google Scholar] [CrossRef]
- Altschul, S. Gapped BLAST and PSI-BLAST: A new generation of protein database search programs. Nucleic Acids Res. 1997, 25, 3389–3402. [Google Scholar] [CrossRef]
- Biello, R.; Mathers, T.C.; Mugford, S.T.; Liu, Q.; Rodrigues, A.S.B.; Neto, A.C.; Rebelo, M.T.; Paulo, O.S.; Seabra, S.G.; Hogenhout, S.A. Draft Genome Assembly Version 1 of the Meadow Spittlebug Philaenus spumarius (Linnaeus, 1758) (Hemiptera, Aphrophoridae). Available online: https://zenodo.org/record/3368385 (accessed on 23 October 2022).
- Hunter, W.B.; Lapointe, S.L.; Sinisterra, X.H.; Achor, D.S.; Funk, C.J. Iridovirus in the root weevil Diaprepes abbreviatus. J. Insect Sci. 2003, 3, 6. [Google Scholar] [CrossRef]
- Silva, L.A.; Jordan, C.; de Carvalho, V.R.; Wilcken, C.F.; Ribeiro, B.M. Identification and genome sequencing of RNA viruses in the eucalyptus snout beetle Gonipterus spp. (Coleoptera: Curculionidae). Arch. Virol. 2020, 165, 2993–2997. [Google Scholar] [CrossRef] [PubMed]
- Wegensteiner, R.; Weiser, J. A new entomopoxvirus in the bark beetle Ips typographus (Coleoptera, Scolytidae). J. Invertebr. Pathol. 1995, 65, 203–205. [Google Scholar] [CrossRef]
- Handel, U.; Wegensteiner, R.; Weiser, J.; Zizka, Z. Occurrence of pathogens in associated living bark beetles (Col., Scolytidae) from different spruce stands in Austria. J. Pest Sci. 2003, 76, 22–32. [Google Scholar] [CrossRef]
- Yaman, M.; Baki, H. First record of entomopoxvirus of Ips typographus (Linnaeus) (Coleoptera: Curculionidae, Scolytinae) for Turkey. Acta Zool. Bulg. 2011, 63, 199–202. [Google Scholar]
- Gopinadhan, P.B.; Mohandas, N.; Vasudevan Nair, K.P. Cytoplasmic Polyhedrosis Virus infecting red palm weevil of coconut. Curr. Sci. Assoc. 1990, 59, 5. [Google Scholar]
- Kenyon, L.; Kumar, S.; Tsai, W.-S.; d’A Hughes, J. Virus diseases of peppers (Capsicum spp.) and their control. In Advances in Virus Research, 1st ed.; Maramorosch, K., Murphy, F., Shatkin, A., Eds.; Elsevier: Amsterdam, The Netherlands, 2014; Volume 62, pp. 297–354. [Google Scholar]
- St. Leger, R.J.; Wang, C. Genetic engineering of fungal biocontrol agents to achieve greater efficacy against insect pests. Appl. Microbiol. Biotechnol. 2010, 85, 901–907. [Google Scholar] [CrossRef]
- Gurulingappa, P.; Sword, G.A.; Murdoch, G.; McGee, P.A. Colonization of crop plants by fungal entomopathogens and their effects on two insect pests when in planta. Biol. Control 2010, 55, 34–41. [Google Scholar] [CrossRef]
- Posada-Flórez, F.J. Production of Beauveria bassiana fungal spores on rice to control the coffee berry borer, Hypothenemus hampei, in Colombia. J. Insect Sci. 2008, 8, 41. [Google Scholar] [CrossRef]
- Yasuda, K. Auto-infection system for the sweet potato weevil, Cylas formicarius (Fabricius) (Coleoptera: Curculionidae) with entomopathogenic fungi, Beauveria bassiana using a modified sex pheromone trap in the field. Appl. Entomol. Zool. 1999, 34, 501–505. [Google Scholar] [CrossRef]
- Kumar, V.; Singh, G.P.; Babu, A.M.; Ahsan, M.M.; Datta, R.K. Germination, penetration, and invasion of Beauveria bassiana on silkworm, Bombyx mori, causing white muscardine. Ital. J. Zool. 1999, 66, 39–43. [Google Scholar] [CrossRef]
- Godonou, I.; Green, K.R.; Oduro, K.A.; Lomer, C.J.; Afreh-Nuamah, K. Field evaluation of selected formulations of Beauveria bassiana for the management of the banana weevil (Cosmopolites sordidus) on plantain (Musa spp., AAB group). Biocontrol Sci. Technol. 2000, 10, 779–788. [Google Scholar] [CrossRef]
- Tinzaara, W.; Gold, C.S.; Dicke, M.; Van Huis, A.; Nankinga, C.M.; Kagezi, G.H.; Ragama, P.E. The use of aggregation pheromone to enhance dissemination of Beauveria bassiana for the control of the banana weevil in Uganda. Biocontrol Sci. Technol. 2007, 17, 111–124. [Google Scholar] [CrossRef]
- Fancelli, M.; Batista Dias, A.; Delalibera Júnior, I.; Cerqueira de Jesus, S.; Souza do Nascimento, A.; de Oliveira e Silva, S.; Correa Caldas, R.; da Silva Ledo, C.A. Beauveria bassiana strains for biological control of Cosmopolites sordidus (Germ.) (Coleoptera: Curculionidae) in plantain. BioMed Res. Int. 2013, 2013, 184756. [Google Scholar] [CrossRef] [PubMed]
- Mc Namara, L.; Dolan, S.K.; Walsh, J.M.D.; Stephens, J.C.; Glare, T.R.; Kavanagh, K.; Griffin, C.T. Oosporein, an abundant metabolite in Beauveria caledonica, with a feedback induction mechanism and a role in insect virulence. Fungal Biol. 2019, 123, 601–610. [Google Scholar] [CrossRef]
- Mc Namara, L.; Carolan, J.C.; Griffin, C.T.; Fitzpatrick, D.; Kavanagh, K. The Effect of entomopathogenic fungal culture filtrate on the immune response of the greater wax moth, Galleria mellonella. J. Insect Physiol. 2017, 100, 82–92. [Google Scholar] [CrossRef]
- Membang, G.; Ambang, Z.; Mahot, H.C.; Kuate, A.F.; Fiaboe, K.K.M.; Hanna, R. Cosmopolites sordidus (Germar) susceptibility to indigenous Cameroonian Beauveria bassiana (Bals.) Vuill. and Metarhizium anisopliae (Metsch.) isolates. J. Appl. Entomol. 2020, 144, 468–480. [Google Scholar] [CrossRef]
- Cornara, D.; Cavalieri, V.; Dongiovanni, C.; Altamura, G.; Palmisano, F.; Bosco, D.; Porcelli, F.; Almeida, R.P.P.; Saponari, M. Transmission of Xylella fastidiosa by naturally infected Philaenus spumarius (Hemiptera, Aphrophoridae) to different host plants. J. Appl. Entomol. 2017, 141, 80–87. [Google Scholar] [CrossRef]
- Ganassi, S.; Di Domenico, C.; Altomare, C.; Samuels, G.J.; Grazioso, P.; Cillo, P.D.; Pietrantonio, L.; De Cristofaro, A. Potential of fungi of the genus Trichoderma for biocontrol of Philaenus spumarius, the insect vector for the quarantine bacterium Xylella fastidosa. Pest Manag. Sci. 2022, 79, 719–728. [Google Scholar] [CrossRef]
- Germinara, G.S.; Ganassi, S.; Pistillo, M.O.; Di Domenico, C.; De Cristofaro, A.; Di Palma, A.M. Antennal olfactory responses of adult meadow spittlebug, Philaenus spumarius, to volatile organic compounds (VOCs). PLoS ONE 2017, 12, e0190454. [Google Scholar] [CrossRef]
- Evidente, A.; Andolfi, A.; Cimmino, A.; Ganassi, S.; Altomare, C.; Favilla, M.; De Cristofaro, A.; Vitagliano, S.; Agnese Sabatini, M. Bisorbicillinoids produced by the fungus Trichoderma citrinoviride affect feeding preference of the aphid Schizaphis graminum. J. Chem. Ecol. 2009, 35, 533–541. [Google Scholar] [CrossRef]
- Ganassi, S.; Grazioso, P.; De Cristofaro, A.; Fiorentini, F.; Sabatini, M.A.; Evidente, A.; Altomare, C. Long chain alcohols produced by Trichoderma citrinoviride have phagodeterrent activity against the bird cherry-oat aphid Rhopalosiphum padi. Front. Microbiol. 2016, 7, 297. [Google Scholar] [CrossRef] [PubMed]
- Asensio, L.; Carbonell, T.; López-Jiménez, J.A.; Lopez-Llorca, L.V. Entomopathogenic fungi in soils from Alicante province. Span. J. Agric. Res. 2003, 1, 9. [Google Scholar] [CrossRef]
- Lozano-Soria, A.; Picciotti, U.; Lopez-Moya, F.; Lopez-Cepero, J.; Porcelli, F.; Lopez-Llorca, L.V. Volatile organic compounds from entomopathogenic and nematophagous fungi, repel banana black weevil (Cosmopolites sordidus). Insects 2020, 11, 509. [Google Scholar] [CrossRef] [PubMed]
- Zimmermann, G. Review on safety of the entomopathogenic fungi Beauveria bassiana and Beauveria brongniartii. Biocontrol Sci. Technol. 2007, 17, 553–596. [Google Scholar] [CrossRef]
- Lopez-Llorca, L.V. Thrips affected by entomopathogenic fungus Beauveria bassiana. Phytoma Esp. 1993, 53, 41–43. [Google Scholar]
- Lopez-Llorca, L. Aphid infection by the entomopathogen Erynia neoaphidis—SEM study. Mycologist 1993, 7, 166–168. [Google Scholar] [CrossRef]
- Lopez-Llorca, L.V.; Carbonell, T.; Gomez-Vidal, S. Degradation of insect cuticle by Paecilomyces farinosus proteases. Mycol. Prog. 2002, 1, 249–256. [Google Scholar] [CrossRef]
- Güerri-Agulló, B.; Gómez-Vidal, S.; Asensio, L.; Barranco, P.; Lopez-Llorca, L.V. Infection of the red palm weevil (Rhynchophorus ferrugineus) by the entomopathogenic fungus Beauveria bassiana: A SEM study. Microsc. Res. Technol. 2010, 73, 714–725. [Google Scholar]
- Ricaño, J.; Güerri-Agulló, B.; Serna-Sarriás, M.J.; Rubio-Llorca, G.; Asensio, L.; Barranco, P.; Lopez-Llorca, L.V. Evaluation of the pathogenicity of multiple isolates of Beauveria bassiana (Hypocreales: Clavicipitaceae) on Rhynchophorus ferrugineus (Coleoptera: Dryophthoridae) for the assessment of a solid formulation under simulated field conditions. Fla. Entomol. 2013, 96, 1311–1324. [Google Scholar] [CrossRef]
- Güerri-Agulló, B.; López-Follana, R.; Asensio, L.; Barranco, P.; Lopez-Llorca, L.V. Use of a solid formulation of Beauveria bassiana for biocontrol of the red palm weevil (Rhynchophorus ferrugineus) (Coleoptera: Dryophthoridae) under field conditions in SE Spain. Fla. Entomol. 2011, 94, 737–7472. [Google Scholar] [CrossRef]
- Aguilera Sammaritano, J.A.; López Lastra, C.C.; Leclerque, A.; Vazquez, F.; Toro, M.E.; D’Alessandro, C.P.; Cuthbertson, A.G.S.; Lechner, B.E. Control of Bemisia tabaci by entomopathogenic fungi isolated from arid soils in Argentina. Biocontrol Sci. Technol. 2016, 26, 1668–1682. [Google Scholar] [CrossRef]
- Casique-Valdés, R.; Torres-Acosta, R.I.; Sánchez-Peña, S.R. Metarhizium acridum and other entomopathogenic fungi from grasshoppers at arid sites of northeastern Mexico. Southwest. Entomol. 2022, 47, 547–558. [Google Scholar] [CrossRef]
- Lopez-Llorca, L.V.; Carbonell, T.; Salinas, J. Colonization of plant waste substrates by entomopathogenic and mycoparasitic fungi—A SEM study. Micron 1999, 30, 325–333. [Google Scholar] [CrossRef]
- Asensio, L.; López-Jiménez, J.Á.; López-Llorca, L.V. Mycobiota of the date palm phylloplane: Description and interactions. Rev. Iberoam. Micol. 2007, 24, 299–304. [Google Scholar] [CrossRef]
- Gómez-Vidal, S.; Lopez-Llorca, L.V.; Jansson, H.-B.; Salinas, J. Endophytic colonization of date palm (Phoenix dactylifera L.) leaves by entomopathogenic fungi. Micron 2006, 37, 624–632. [Google Scholar] [CrossRef]
- Mohamed Mahmoud, F.; Krimi, Z.; Maciá-Vicente, J.G.; Brahim Errahmani, M.; Lopez-Llorca, L.V. Endophytic fungi associated with roots of date palm (Phoenix dactylifera) in coastal dunes. Rev. Iberoam. Micol. 2017, 34, 116–120. [Google Scholar] [CrossRef] [PubMed]
- Hu, S.; Bidochka, M.J. Root colonization by endophytic insect-pathogenic fungi. J. Appl. Microbiol. 2021, 130, 570–581. [Google Scholar] [CrossRef] [PubMed]
- Philippot, L.; Raaijmakers, J.M.; Lemanceau, P.; van der Putten, W.H. Going back to the roots: The microbial ecology of the rhizosphere. Nat. Rev. Microbiol. 2013, 11, 789–799. [Google Scholar] [CrossRef] [PubMed]
- Aranda-Martinez, A.; Naranjo Ortiz, M.Á.; Abihssira García, I.S.; Zavala-Gonzalez, E.A.; Lopez-Llorca, L.V. Ethanol production from chitosan by the nematophagous fungus Pochonia chlamydosporia and the entomopathogenic fungi Metarhizium anisopliae and Beauveria bassiana. Microbiol. Res. 2017, 204, 30–39. [Google Scholar] [CrossRef]
- González-Mas, N.; Gutiérrez-Sánchez, F.; Sánchez-Ortiz, A.; Grandi, L.; Turlings, T.C.J.; Manuel Muñoz-Redondo, J.; Moreno-Rojas, J.M.; Quesada-Moraga, E. Endophytic colonization by the entomopathogenic fungus Beauveria bassiana affects plant volatile emissions in the presence or absence of chewing and sap-sucking insects. Front. Plant Sci. 2021, 12, 660460. [Google Scholar] [CrossRef]
- Rivas-Franco, F.; Hampton, J.G.; Altier, N.A.; Swaminathan, J.; Rostás, M.; Wessman, P.; Saville, D.J.; Jackson, T.A.; Jackson, M.A.; Glare, T.R. Production of microsclerotia from entomopathogenic fungi and use in maize seed coating as delivery for biocontrol against fusarium Graminearum. Front. Sustain. Food Syst. 2020, 4, 606828. [Google Scholar] [CrossRef]
- Mathulwe, L.L.; Malan, A.P.; Stokwe, N.F. Mass production of entomopathogenic fungi, Metarhizium robertsii and Metarhizium pinghaense, for commercial application against insect pests. J. Vis. Exp. 2022, 181, e63246. [Google Scholar]
- Gómez-Vidal, S.; Salinas, J.; Tena, M.; Lopez-Llorca, L.V. Proteomic analysis of date palm (Phoenix dactylifera L.) responses to endophytic colonization by entomopathogenic fungi. Electrophoresis 2009, 30, 2996–3005. [Google Scholar] [CrossRef] [PubMed]
- Pusztahelyi, T. Chitin and chitin-related compounds in plant–fungal interactions. Mycology 2018, 9, 189–201. [Google Scholar] [CrossRef]
- Palma-Guerrero, J.; Huang, I.-C.; Jansson, H.-B.; Salinas, J.; Lopez-Llorca, L.V.; Read, N.D. Chitosan permeabilizes the plasma membrane and kills cells of Neurospora crassa in an energy dependent manner. Fungal Genet. Biol. 2009, 46, 585–594. [Google Scholar] [CrossRef] [PubMed]
- Lopez-Moya, F.; Suarez-Fernandez, M.; Lopez-Llorca, L. Molecular mechanisms of chitosan interactions with fungi and plants. Int. J. Mol. Sci. 2019, 20, 332. [Google Scholar] [CrossRef] [PubMed]
- Lopez-Nuñez, R.; Suarez-Fernandez, M.; Lopez-Moya, F.; Lopez-Llorca, L.V. Chitosan and nematophagous fungi for sustainable management of nematode pests. Front. Fungal Biol. 2022, 3, 980341. [Google Scholar] [CrossRef]
- Aranda-Martinez, A.; Lopez-Moya, F.; Lopez-Llorca, L.V. Cell wall composition plays a key role on sensitivity of filamentous fungi to chitosan: Role of fungal cell wall on sensitivity to chitosan. J. Basic Microbiol. 2016, 56, 1059–1070. [Google Scholar] [CrossRef]
- Lopez-Moya, F.; Lopez-Llorca, L. Omics for investigating chitosan as an antifungal and gene modulator. J. Fungi 2016, 2, 11. [Google Scholar] [CrossRef]
- Escudero, N.; Ferreira, S.R.; Lopez-Moya, F.; Naranjo-Ortiz, M.A.; Marin-Ortiz, A.I.; Thornton, C.R.; Lopez-Llorca, L.V. Chitosan enhances parasitism of Meloidogyne javanica eggs by the nematophagous fungus Pochonia chlamydosporia. Fungal Biol. 2016, 120, 572–585. [Google Scholar] [CrossRef]
- Escudero, N.; Lopez-Moya, F.; Ghahremani, Z.; Zavala-Gonzalez, E.A.; Alaguero-Cordovilla, A.; Ros-Ibañez, C.; Lacasa, A.; Sorribas, F.J.; Lopez-Llorca, L.V. Chitosan increases tomato root colonization by Pochonia chlamydosporia and their combination reduces root-knot nematode damage. Front. Plant Sci. 2017, 8, 1415. [Google Scholar]
- Suarez-Fernandez, M.; Sambles, C.; Lopez-Moya, F.; Nueda, M.J.; Studholme, D.J.; Lopez-Llorca, L.V. Chitosan modulates Pochonia chlamydosporia gene expression during nematode egg parasitism. Environ. Microbiol. 2021, 23, 4980–4997. [Google Scholar] [CrossRef] [PubMed]
- Lin, R.; Qin, F.; Shen, B.; Shi, Q.; Liu, C.; Zhang, X.; Jiao, Y.; Lu, J.; Gao, Y.; Suarez-Fernandez, M.; et al. Genome and secretome analysis of Pochonia chlamydosporia provide new insight into egg-parasitic mechanisms. Sci. Rep. 2018, 8, 1123. [Google Scholar] [CrossRef]
- Jalinas, J.; Guerri-Agullo, B.; Mankin, R.W.; Lopez-Follana, R.; Lopez-Llorca, L.V. Acoustic assessment of Beauveria Bassiana (Hypocreales: Clavicipitaceae) effects on Rhynchophorus ferrugineus (Coleoptera: Dryophthoridae) larval activity and mortality. J. Econ. Entomol. 2015, 108, 444–453. [Google Scholar] [CrossRef] [PubMed]
- Jalinas, J.; Lopez-Moya, F.; Marhuenda-Egea, F.C.; Lopez-Llorca, L.V. Beauveria bassiana (Hypocreales: Clavicipitaceae) volatile organic compounds (VOCs) repel Rhynchophorus ferrugineus (Coleoptera: Dryophthoridae). J. Fungi 2022, 8, 843. [Google Scholar] [CrossRef] [PubMed]
- Elias, G.A.; dos Santos, R. Produtos florestais não madeireiros e valor potencial de exploração sustentável da Floresta Atlântica no sul de Santa Catarina. Ciênc. Florest. 2016, 26, 249–262. [Google Scholar] [CrossRef]
- Elias, G.A.; dos Santos, R.; Citadini-Zanette, V.; Corrêa, P. Arecaceae: Análise bibliométrica das espécies nativas do estado de Santa Catarina. Ciênc. E Nat. 2015, 37, 85–92. [Google Scholar]
- Ferreira, J.M.S.; Warwick, D.R.N.; Siqueira, L.A. A Cultura do Coqueiro no Brasil; Embrapa: Brasília, Brazil; Serviço de Produção e Informação: Brasília, Brazil, 1998. [Google Scholar]
- Dalbon, V.A.; Acevedo, J.P.M.; Ribeiro Junior, K.A.L.; Ribeiro, T.F.L.; da Silva, J.M.; Fonseca, H.G.; Santana, A.E.G.; Porcelli, F. Perspectives for synergic blends of attractive sources in south american palm weevil mass trapping: Waiting for the red palm weevil Brazil invasion. Insects 2021, 12, 828. [Google Scholar] [PubMed]
- Wattanapongsiri, A. A Revision of the Genera Rhynchophorus and Dynamis (Coleoptera: Curculionidae). Ph.D. Thesis, Oregon State University, Corvallis, OR, USA, 1966. [Google Scholar]
- Vásquez-Ordóñez, A.A.; Löhr, B.L.; Marvaldi, A.E. Comparative morphology of the larvae of the palm weevils Dynamis borassi (Fabricius) and Rhynchophorus palmarum (Linnaeus) (Curculionidae: Dryophthorinae): Two major pests of peach palms in the Neotropics. Papéis Avulsos Zool. 2020, 60, e202060. [Google Scholar]
- Couturier, G.; O’Brien, C.W.; Kahn, F. Astrocaryum carnosum and A. chonta (Palmae), new host for the weevil Dynamis borassi (Curculionidae: Rhynchophorinae). Principes 1998, 42, 227–228. [Google Scholar]
- EPPO Global Database Rhynchophorus palmarum (RHYCPA). Available online: https://gd.eppo.int/taxon/RHYCPA/documents (accessed on 31 August 2022).
- Gerber, K.; Giblin-Davis, R.M. Association of the red ring nematode and other nematode species with the palm weevil, Rhynchophorus palmarum. J. Nematoiogy 1990, 22, 143–149. [Google Scholar]
- Giblin-Davis, R.M.; Davies, K.A.; Morris, K.; Thomas, W.K. Evolution of parasitism in insect-transmitted plant nematodes. J. Nematol. 2003, 35, 133. [Google Scholar] [PubMed]
- Duarte, A.G.; de Lima, I.S.; do Amaral Ferraz Navarro, D.M.; Goulart Sant’ana, A.E. Captura de Rhynchophorus palmarum L. (Coleoptera: Curculionidae) em armadilhas iscadas com o feromônio de agregação e compostos voláteis de frutos do abacaxi. Rev. Bras. Frutic. 2003, 25, 81–84. [Google Scholar] [CrossRef]
- Moura, J.I.L.; Resende, M.L.V.; Sgrillo, R.; Nascimento, L.A.; Romano, R. Diferente tipos de armadilhas de iscas no controle de Rhynchophorus palmarum L. (Coleóptera: Curculionidae). Agrotrópica 1990, 2, 165–169. [Google Scholar]
- Rochat, D.; Malosse, C.; Lettere, M.; Ducrot, P.-H.; Zigatti, P.; Renou, M.; Descoins, C. The American palm weevil, Rhynchophorus palmarum (L.) (Coleoptera, Curculionidae). J. Chem. Ecol. 1991, 17, 2127–2141. [Google Scholar] [CrossRef]
- Sanjuan, T.; Tabima, J.; Restrepo, S.; Læssøe, T.; Spatafora, J.W.; Franco-Molano, A.E. Entomopathogens of Amazonian stick insects and locusts are members of the Beauveria species complex (Cordyceps sensu stricto). Mycologia 2014, 106, 260–275. [Google Scholar] [CrossRef]
- Alves, S.B.; Moraes, S.A. Quantificação de inóculo de patógenos de insetos. In Controle Microbiano de Insetos, 2nd ed; Biblioteca De Ciências Agrárias Luiz De Queiroz: São Paulo, Brazil, 1998; Volume 4, pp. 765–778. [Google Scholar]
- McGuire, A.V.; Northfield, T.D. Tropical occurrence and agricultural importance of Beauveria bassiana and Metarhizium anisopliae. Front. Sustain. Food Syst. 2020, 4, 6. [Google Scholar] [CrossRef]
- Goettel, M.S.; Leger, R.J.S.; Bhairi, S.; Jung, M.K.; Oakley, B.R.; Roberts, D.W.; Staples, R.C. Pathogenicity and growth of Metarhizium anisopliae stably transformed to benomyl resistance. Curr. Genet. 1990, 17, 129–132. [Google Scholar] [CrossRef]
- Yasin, M.; Wakil, W.; Qayyum, M.A.; Ali, S.; Sajjad, A.; Aqueel, M.A.; Shakeel, M. Biocontrol potential of entomopathogenic fungi, nematodes and bacteria against Rhynchophorus ferrugineus (Olivier). Egypt. J. Biol. Pest Control 2021, 31, 138. [Google Scholar] [CrossRef]
- Joop, G.; Vilcinskas, A. Coevolution of parasitic fungi and insect hosts. Zoology 2016, 119, 350–358. [Google Scholar] [CrossRef]
- Wang, C.; Wang, S. Insect pathogenic fungi: Genomics, molecular interactions, and genetic improvements. Annu. Rev. Entomol. 2017, 62, 73–90. [Google Scholar] [CrossRef] [PubMed]
- Mascarin, G.M.; Lopes, R.B.; Delalibera, Í.; Fernandes, É.K.K.; Luz, C.; Faria, M. Current status and perspectives of fungal entomopathogens used for microbial control of arthropod pests in Brazil. J. Invertebr. Pathol. 2019, 165, 46–53. [Google Scholar] [CrossRef] [PubMed]
- Ministério da Agricultura, Pecuária e Abastecimento. Agrofit—Sistema de Agrotóxicos Fitossanitários. Available online: http://agrofit.agricultura.gov.br/agrofit_cons/principal_agrofit_cons (accessed on 31 August 2022).
- McKinnon, A.C.; Glare, T.R.; Ridgway, H.J.; Mendoza-Mendoza, A.; Holyoake, A.; Godsoe, W.K.; Bufford, J.L. Detection of the entomopathogenic fungus Beauveria bassiana in the rhizosphere of wound-stressed Zea mays plants. Front. Microbiol. 2018, 9, 1161. [Google Scholar] [CrossRef] [PubMed]
- León-Martínez, G.A.; Campos-Pinzón, J.C.; Arguelles-Cárdenas, J.H. patogenicidad y autodiseminación de cepas promisorias de hongos entomopatógenos sobre Rhynchophorus palmarum L. (Coleoptera: Dryophthoridae). Agron. Mesoam. 2019, 30, 631–646. [Google Scholar] [CrossRef]
- Kindermann, J.; El-Ayouti, Y.; Samuels, G.J.; Kubicek, C.P. Phylogeny of the genus Trichoderma Based on sequence analysis of the internal transcribed spacer region 1 of the rDNA cluster. Fungal Genet. Biol. 1998, 24, 298–309. [Google Scholar] [CrossRef] [PubMed]
- Rehner, S.A.; Minnis, A.M.; Sung, G.-H.; Luangsa-ard, J.J.; Devotto, L.; Humber, R.A. Phylogeny and systematics of the anamorphic, entomopathogenic genus Beauveria. Mycologia 2011, 103, 1055–1073. [Google Scholar] [CrossRef] [PubMed]
- Imoulan, A.; Hussain, M.; Kirk, P.M.; El Meziane, A.; Yao, Y.-J. Entomopathogenic fungus Beauveria: Host specificity, ecology and significance of morpho-molecular characterization in accurate taxonomic classification. J. Asia-Pac. Entomol. 2017, 20, 1204–1212. [Google Scholar] [CrossRef]
- Bustamante, D.E.; Oliva, M.; Leiva, S.; Mendoza, J.E.; Bobadilla, L.; Angulo, G.; Calderon, M.S. Phylogeny and species delimitations in the entomopathogenic genus Beauveria (Hypocreales, Ascomycota), including the description of B. peruviensis sp. nov. MycoKeys 2019, 58, 47–68. [Google Scholar] [CrossRef]
- Castro-Vásquez, R.M.; Molina-Bravo, R.; Hernández-Villalobos, S.; Vargas-Martínez, A.; González-Herrera, A.; Montero-Astúa, M. identification and phylogenetic analysis of a collection of Beauveria spp. isolates from Central America and Puerto Rico. J. Invertebr. Pathol. 2021, 184, 107642. [Google Scholar] [CrossRef]
- Fiorino, P. Olea: Trattato di Olivicoltura; Edagricole—New Business Media: Milan, Italy, 2003; p. 480. [Google Scholar]
- Ali, N.; Chapuis, E.; Tavoillot, J.; Mateille, T. Plant-parasitic nematodes associated with olive tree (Olea europaea L.) with a focus on the Mediterranean Basin: A review. Comptes Rendus Biol. 2014, 337, 423–442. [Google Scholar] [CrossRef]
- Chliyeh, M.; Touati, J.; Selmaoui, K.; Touhami, A.O.; Filali, A.; Modafar, C.E.; Moukhli, A.; Benkirane, R.; Douira, A. Bibliographic inventory of the olive tree (Olea europaea L.) fungal diseases in the world. Int. J. Pure Appl. Biosci. 2014, 2, 46–79. [Google Scholar]
- Dimou, I.; Rempoulakis, P.; Economopoulos, A.P. Olive fruit fly [Bactrocera (Dacus) oleae (Rossi) (Diptera: Tephritidae)] adult rearing diet without antibiotic. J. Appl. Entomol. 2010, 134, 72–79. [Google Scholar] [CrossRef]
- Besnard, G.; Terral, J.-F.; Cornille, A. On the origins and domestication of the olive: A review and perspectives. Ann. Bot. 2018, 121, 385–403. [Google Scholar] [CrossRef] [PubMed]
- Cacciola, S.O.; Faedda, R.; Sinatra, F.; Agosteo, G.E.; Schena, L.; Frisullo, S.; Magnano di San Lio, G. Olive anthracnose. J. Plant Pathol. 2012, 94, 29–44. [Google Scholar]
- Schena, L.; Mosca, S.; Cacciola, S.O.; Faedda, R.; Sanzani, S.M.; Agosteo, G.E.; Sergeeva, V.; Magnano di San Lio, G. Species of the Colletotrichum gloeosporioides and C. boninense complexes associated with olive anthracnose. Plant Pathol. 2014, 63, 437–4460. [Google Scholar] [CrossRef]
- Eigenbrode, S.D.; Bosque-Pérez, N.A.; Davis, T.S. Insect-borne plant pathogens and their vectors: Ecology, evolution, and complex interactions. Annu. Rev. Entomol. 2018, 63, 169–191. [Google Scholar] [CrossRef] [PubMed]
- Ghelardini, L.; Pepori, A.L.; Luchi, N.; Capretti, P.; Santini, A. Drivers of emerging fungal diseases of forest trees. For. Ecol. Manag. 2016, 381, 235–246. [Google Scholar] [CrossRef]
- Solinas, M. Osservazioni biologiche condotte in Puglia sulla Prolasioptera berlesiana Paoli, con particolare riferimento ai rapporti simbiotici col Dacus oleae Gmel. e con la Sphaeropsis dalmatica (Thüm.) Gigante. Entomologica 1967, 3, 129–176. [Google Scholar]
- Moral, J.; Trapero, A. Assessing the susceptibility of olive cultivars to anthracnose caused by Colletotrichum acutatum. Plant Dis. 2009, 93, 1028–1036. [Google Scholar] [CrossRef]
- Koronéos, J. Les Insectes de l’Olivier Dans Le Pélion: Observations Biologiques Sur Le Lasioptera. A Prociphilus Living on the Oleaceae in Greece; Imprimerie “Steph. Taroussopoulos,”: Athens, Greece, 1939. [Google Scholar]
- Nicoletti, R.; Becchimanzi, A. Ecological and molecular interactions between insects and fungi. Microorganisms 2022, 10, 96. [Google Scholar] [CrossRef]
- Gutierrez, A.P.; Ponti, L.; Cossu, Q.A. Effects of climate warming on olive and olive fly (Bactrocera oleae (Gmelin)) in California and Italy. Clim. Chang. 2009, 95, 195–217. [Google Scholar] [CrossRef]
- Vizzarri, V.; Tosi, L. Phytopathological problems and phytosanitary aspects of olive in central-southern Italy: Known and newly emerging threats. Olivae 2015, 122, 34–44. [Google Scholar]
- Girolami, V. Reperti morfo-istologici sulle batteriosimbiosi del Dacus oleae Gmelin e di altri ditteri tripetidi, in natura e negli allevamenti su substrati artificiali. Redia 1973, 54, 269–294. [Google Scholar]
- Capuzzo, C.; Firrao, G.; Mazzon, L.; Squartini, A.; Girolami, V. ‘Candidatus Erwinia dacicola’, a coevolved symbiotic bacterium of the olive fly Bactrocera oleae (Gmelin). Int. J. Syst. Evol. Microbiol. 2005, 55, 1641–1647. [Google Scholar] [CrossRef] [PubMed]
- Savio, C.; Mazzon, L.; Martinez-Sañudo, I.; Simonato, M.; Squartini, A.; Girolami, V. Evidence of two lineages of the symbiont ‘Candidatus Erwinia dacicola’ in Italian populations of Bactrocera oleae (Rossi) based on 16S rRNA gene sequences. Int. J. Syst. Evol. Microbiol. 2012, 62, 179–187. [Google Scholar] [CrossRef] [PubMed]
- Estes, A.M.; Nestel, D.; Belcari, A.; Jessup, A.; Rempoulakis, P.; Economopoulos, A.P. A basis for the renewal of sterile insect technique for the olive fly, Bactrocera oleae (Rossi): Olive fly SIT. J. Appl. Entomol. 2012, 136, 1–16. [Google Scholar] [CrossRef]
- Estes, A.M.; Hearn, D.J.; Burrack, H.J.; Rempoulakis, P.; Pierson, E.A. Prevalence of Candidatus Erwinia dacicola in wild and laboratory olive fruit fly populations and across developmental stages. Environ. Entomol. 2012, 41, 265–274. [Google Scholar] [CrossRef]
- Hagen, K.S. Dependence of the olive fly, Dacus oleae, larvae on symbiosis with Pseudomonas savastanoi for the utilization of olive. Nature 1966, 209, 423–424. [Google Scholar] [CrossRef]
- Lambrou, P.D.; Tzanakakis, M.E. Inhibition of larval growth of Dacus oleae (Diptera: Tephritidae) by streptomycin II. Effect of treating the parents. Entomol. Exp. Appl. 1978, 23, 163–170. [Google Scholar] [CrossRef]
- Boucias, D.G.; Lietze, V.-U.; Teal, P. Chemical signals that mediate insect-fungal interactions. In Biocommunication of Fungi; Witzany, G., Ed.; Springer: Dordrecht, The Netherlands, 2012; pp. 305–336. [Google Scholar]
- Six, D.L. Ecological and evolutionary determinants of bark beetle–fungus symbioses. Insects 2012, 3, 339–366. [Google Scholar] [CrossRef]
- Kellner, K.; Fernández-Marín, H.; Ishak, H.D.; Sen, R.; Linksvayer, T.A.; Mueller, U.G. Co-evolutionary patterns and diversification of ant-fungus associations in the asexual fungus-farming ant Mycocepurus smithii in Panama. J. Evol. Biol. 2013, 26, 1353–1362. [Google Scholar] [CrossRef] [PubMed]
- Janson, E.M.; Peeden, E.R.; Stireman, J.O.; Abbot, P. Symbiont-mediated phenotypic variation without co-evolution in an insect–fungus association. J. Evol. Biol. 2010, 23, 2212–2228. [Google Scholar] [CrossRef] [PubMed]
- Willsey, T.; Chatterton, S.; Cárcamo, H. Interactions of root-feeding insects with fungal and oomycete plant pathogens. Front. Plant Sci. 2017, 8, 1764. [Google Scholar] [CrossRef] [PubMed]
- Sugio, A.; Dubreuil, G.; Giron, D.; Simon, J.-C. Plant-insect interactions under bacterial influence: Ecological implications and underlying mechanisms. J. Exp. Bot. 2015, 66, 467–478. [Google Scholar] [CrossRef]
- Leakey, C.L.A.; Perry, D.A. The relation between damage caused by insect pests and boll rot associated with Glomerella cingulata (Stonem.) Spauld. & von Schrenk (Colletotrichum gossypii Southw.) on upland cotton in Uganda. Ann. Appl. Biol. 1966, 57, 337–344. [Google Scholar]
- Maffei, M.E.; Mithöfer, A.; Boland, W. Insects feeding on plants: Rapid signals and responses preceding the induction of phytochemical release. Phytochemistry 2007, 68, 2946–2959. [Google Scholar] [CrossRef]
- Kluth, S.; Kruess, A.; Tscharntke, T. Insects as vectors of plant pathogens: Mutualistic and antagonistic interactions. Oecologia 2002, 133, 193–199. [Google Scholar] [CrossRef] [PubMed]
- Huang, W.; Reyes-Caldas, P.; Mann, M.; Seifbarghi, S.; Kahn, A.; Almeida, R.P.P.; Béven, L.; Heck, M.; Hogenhout, S.A.; Coaker, G. Bacterial vector-borne plant diseases: Unanswered questions and future directions. Mol. Plant 2020, 13, 1379–1393. [Google Scholar] [CrossRef] [PubMed]
- Whitfield, A.E.; Falk, B.W.; Rotenberg, D. Insect vector-mediated transmission of plant viruses. Virology 2015, 479–480, 278–289. [Google Scholar] [CrossRef]
- Weintraub, P.G. Insect vectors of phytoplasmas and their control—An update. Bull. Insectology 2007, 60, 169–173. [Google Scholar]
- Gurung, K.; Wertheim, B.; Falcao Salles, J. The microbiome of pest insects: It is not just bacteria. Entomol. Exp. Appl. 2019, 167, 156–170. [Google Scholar] [CrossRef]
- Picciotti, U.; Lahbib, N.; Sefa, V.; Porcelli, F.; Garganese, F. Aphrophoridae role in Xylella Fastidiosa subsp. pauca ST53 invasion in southern Italy. Pathogens 2021, 10, 1035. [Google Scholar] [CrossRef] [PubMed]
- McHugh, C.P. Arthropods: Vectors of disease agents. Lab. Med. 1994, 25, 429–437. [Google Scholar] [CrossRef]
- Hatcher, P.E. Three-way interactions between plant pathogenic fungi, herbivorous insects and their host plants. Biol. Rev. 1995, 70, 639–694. [Google Scholar] [CrossRef]
- Meldrum, R.A.; Daly, A.M.; Tran-Nguyen, L.T.T.; Aitken, E.A.B. Are banana weevil borers a vector in spreading Fusarium oxysporum f.sp. cubense Tropical Race 4 in banana plantations? Australas. Plant Pathol. 2013, 42, 543–549. [Google Scholar] [CrossRef]
- Guillen Sánchez, C.; Tixier, P.; Tapia Fernández, A.; Conejo Barboza, A.M.; Sandoval Fernández, J.A.; de Lapeyre de Bellaire, L. Can the banana weevil Cosmopolites sordidus be a vector of Fusarium oxysporum f.sp. cubense Race 1? Unravelling the internal and external acquisition of effective inoculum. Pest Manag. Sci. 2021, 77, 3002–3012. [Google Scholar] [CrossRef]
- Miller, L.K.; Ball, L.A. The Insect Viruses (The Viruses); Springer: New York, NY, USA, 1998; p. 434. [Google Scholar]
- Malacrinò, A. Meta-omics tools in the world of insect-microorganism interactions. Biology 2018, 7, 50. [Google Scholar] [CrossRef]
- Malacrinò, A.; Schena, L.; Campolo, O.; Laudani, F.; Mosca, S.; Giunti, G.; Strano, C.P.; Palmeri, V. A Metabarcoding survey on the fungal microbiota associated to the olive fruit fly. Microb. Ecol. 2017, 73, 677–684. [Google Scholar] [CrossRef]
- Muñoz-Benavent, M.; Pérez-Cobas, A.E.; García-Ferris, C.; Moya, A.; Latorre, A. Insects’ potential: Understanding the functional role of their gut microbiome. J. Pharm. Biomed. Anal. 2021, 194, 113787. [Google Scholar] [CrossRef]
- Lahbib, N.; Picciotti, U.; Sefa, V.; Boukhris-Bouhachem, S.; Porcelli, F.; Garganese, F. Zelus renardii roaming in southern Italy. Insects 2022, 13, 158. [Google Scholar] [CrossRef] [PubMed]
- Bubici, G.; Prigigallo, M.I.; Garganese, F.; Nugnes, F.; Jansen, M.; Porcelli, F. First report of Aleurocanthus spiniferus on Ailanthus altissima: Profiling of the insect microbiome and microRNAs. Insects 2020, 11, 161. [Google Scholar] [CrossRef] [PubMed]
- Pavlovic, J.; Cavalieri, D.; Mastromei, G.; Pangallo, D.; Perito, B.; Marvasi, M. MinION technology for microbiome sequencing applications for the conservation of cultural heritage. Microbiol. Res. 2021, 247, 126727. [Google Scholar] [CrossRef] [PubMed]
- Mereghetti, V.; Chouaia, B.; Montagna, M. New insights into the microbiota of moth pests. Int. J. Mol. Sci. 2017, 18, 2450. [Google Scholar] [CrossRef] [PubMed]
- Ben-Yosef, M.; Pasternak, Z.; Jurkevitch, E.; Yuval, B. Symbiotic bacteria enable olive flies (Bactrocera oleae) to exploit intractable sources of nitrogen. J. Evol. Biol. 2014, 27, 2695–2705. [Google Scholar] [CrossRef]
- Ioriatti, C.; Anfora, G.; Tasin, M.; De Cristofaro, A.; Witzgall, P.; Lucchi, A. Chemical ecology and management of Lobesia botrana (Lepidoptera: Tortricidae). J. Econ. Entomol. 2011, 104, 1125–1137. [Google Scholar] [CrossRef] [PubMed]
- Ioriatti, C.; Lucchi, A.; Varela, L.G. Grape berry moths in western european vineyards and their recent movement into the new world. In Arthropod Management in Vineyards; Bostanian, N.J., Vincent, C., Isaacs, R., Eds.; Springer: Dordrecht, The Netherlands, 2012; pp. 339–359. [Google Scholar]
- Dagatti, C.V.; Becerra, V.C. Ajuste de modelo fenológico para predecir el comportamiento de Lobesia botrana (Lepidoptera: Tortricidae) en un viñedo de Mendoza, Argentina. Rev. Soc. Entomológica Argent. 2015, 74, 117–122. [Google Scholar]
- Moschos, T. Yield loss quantification and assessment of economic injury level for the anthophagous generation of the European grapevine moth Lobesia botrana Den. et Schiff. (Lepidoptera: Tortricidae). Int. J. Pest Manag. 2005, 51, 81–89. [Google Scholar] [CrossRef]
- CABI Lobesia botrana (European Grapevine Moth). Available online: https://www.cabidigitallibrary.org/doi/10.1079/cabicompendium.42794 (accessed on 31 August 2022).
- Fermaud, M.; Le Menn, R. Association of Botrytis cinerea with grape berry moth larvae. Phytopathology 1989, 79, 651–656. [Google Scholar] [CrossRef]
- Fermaud, M.; Le Menn, R. Transmission of Botrytis cinerea to grapes by grape berry moth larvae. Phytopathology 1992, 82, 1393–1398. [Google Scholar] [CrossRef]
- Garganese, F.; Sanzani, S.M.; Ligorio, A.; Gennaro, D.D.; Tarricone, L.; Ippolito, A. Effect of irrigation management on field and postharvest quality of organic table grapes. Acta Hortic. 2015, 1144, 273–278. [Google Scholar] [CrossRef]
- Logrieco, A.; Moretti, A.; Perrone, G.; Mulè, G. Biodiversity of complexes of mycotoxigenic fungal species associated with Fusarium ear rot of maize and Aspergillus rot of grape. Int. J. Food Microbiol. 2007, 119, 11–16. [Google Scholar] [CrossRef]
- Cozzi, G.; Somma, S.; Haidukowski, M.; Logrieco, A. Ochratoxin A management in vineyards by Lobesia botrana biocontrol. Toxins 2013, 5, 49–59. [Google Scholar] [CrossRef] [PubMed]
- Kochman, J.; Jakubczyk, K.; Janda, K. Mycotoxins in red wine: Occurrence and risk assessment. Food Control 2021, 129, 108229. [Google Scholar] [CrossRef]
- Fermaud, M.; Giboulot, A. Influence of Lobesia botrana larvae on field severity of Botrytis rot of grape berries. Plant Dis. 1992, 76, 404–409. [Google Scholar] [CrossRef]
- Pavan, F.; Bigot, G.; Cargnus, E.; Zandigiacomo, P. Influence of the carpophagous generations of the European grapevine moth Lobesia botrana on grape bunch rots. Phytoparasitica 2014, 42, 61–69. [Google Scholar] [CrossRef]
- Mondy, N.; Pracros, P.; Fermaud, M.; Corio-Costet, M.-F. Olfactory and gustatory behaviour by larvae of Lobesia botrana in response to Botrytis cinerea. Entomol. Exp. Appl. 1998, 88, 1–7. [Google Scholar] [CrossRef]
- Mondy, N.; Corio-Costet, M.-F. The response of the grape berry moth (Lobesia botrana) to a dietary phytopathogenic fungus (Botrytis cinerea): The significance of fungus sterols. J. Insect Physiol. 2000, 46, 1557–1564. [Google Scholar] [CrossRef] [PubMed]
- Mondy, N.; Corio-Costet, M.-F. Feeding insects with a phytopathogenic fungus influences their diapause and population dynamics. Ecol. Entomol. 2004, 29, 711–717. [Google Scholar] [CrossRef]
- Masante-Roca, I.; Anton, S.; Delbac, L.; Dufour, M.-C.; Gadenne, C. Attraction of the grapevine moth to host and non-host plant parts in the wind tunnel: Effects of plant phenology, sex, and mating status. Entomol. Exp. Appl. 2007, 122, 239–245. [Google Scholar] [CrossRef]
- Tasin, M.; Betta, E.; Carlin, S.; Gasperi, F.; Mattivi, F.; Pertot, I. Volatiles that encode host-plant quality in the grapevine moth. Phytochemistry 2011, 72, 1999–2005. [Google Scholar] [CrossRef]
- Kiaeian Moosavi, F.; Cargnus, E.; Torelli, E.; Bortolomeazzi, R.; Zandigiacomo, P.; Pavan, F. Is the existence of a mutualistic relationship between Lobesia botrana and Botrytis cinerea well-founded? Arch. Insect Biochem. Physiol. 2020, 103, e21655. [Google Scholar] [CrossRef]
- Cozzi, G.; Pascale, M.; Perrone, G.; Visconti, A.; Logrieco, A. Effect of Lobesia botrana damages on black aspergilli rot and ochratoxin A content in grapes. Int. J. Food Microbiol. 2006, 111, S88–S92. [Google Scholar] [CrossRef] [PubMed]
- Clouvel, P.; Bonvarlet, L.; Martinez, A.; Lagouarde, P.; Dieng, I.; Martin, P. Wine contamination by ochratoxin A in relation to vine environment. Int. J. Food Microbiol. 2008, 123, 74–80. [Google Scholar] [CrossRef] [PubMed]
- Cozzi, G.; Haidukowski, M.; Perrone, G.; Visconti, A.; Logrieco, A. Influence of Lobesia botrana field control on black aspergilli rot and ochratoxin A contamination in grapes. J. Food Prot. 2009, 72, 894–897. [Google Scholar] [CrossRef] [PubMed]
- Garganese, F.; Schena, L.; Siciliano, I.; Prigigallo, M.I.; Spadaro, D.; Grassi, A.D.; Ippolito, A.; Sanzani, S.M. Characterization of citrus-associated Alternaria species in Mediterranean areas. PLoS ONE 2016, 11, e0163255. [Google Scholar] [CrossRef]
- Mincuzzi, A.; Ippolito, A.; Montemurro, C.; Sanzani, S.M. Characterization of Penicillium s.s. and Aspergillus Sect. Nigri causing postharvest rots of pomegranate fruit in southern Italy. Int. J. Food Microbiol. 2020, 314, 108389. [Google Scholar] [CrossRef] [PubMed]
- WHO; IARC. Some naturally occurring substances: Food items and constituents, heterocyclic aromatic amines and mycotoxins. In IARC Monographs on the Evaluation of the Carcinogenic Risks to Humans; IARC: Lyon, France, 1993; Volume 56, pp. 489–521. [Google Scholar]
- Perrone, G.; Mulè, G.; Susca, A.; Battilani, P.; Pietri, A.; Logrieco, A. Ochratoxin A production and amplified fragment length polymorphism analysis of Aspergillus carbonarius, Aspergillus tubingensis, and Aspergillus niger strains isolated from grapes in Italy. Appl. Environ. Microbiol. 2006, 72, 680–685. [Google Scholar] [CrossRef]
- Varga, J.; Juhász, A.; Kevei, F.; Kozakiewicz, Z. Molecular diversity of agriculturally important Aspergillus species. Eur. J. Plant Pathol. 2004, 110, 627–640. [Google Scholar] [CrossRef]
- Logrieco, A.; Ferracane, R.; Haidukowsky, M.; Cozzi, G.; Visconti, A.; Ritieni, A. Fumonisin B2 production by Aspergillus niger from grapes and natural occurrence in must. Food Addit. Contam. Part A 2009, 26, 1495–1500. [Google Scholar] [CrossRef] [PubMed]
- Somma, S.; Perrone, G.; Logrieco, A.F. Diversity of black aspergilli and mycotoxin risks in grape, wine and dried vine fruits. Phytopathol. Mediterr. 2012, 51, 131–147. [Google Scholar]
- Visconti, A.; Perrone, G.; Cozzi, G.; Solfrizzo, M. Managing ochratoxin A risk in the grape-wine food chain. Food Addit. Contam. Part A 2008, 25, 193–202. [Google Scholar] [CrossRef] [PubMed]
- Cuthbertson, A.G.S. Unnecessary pesticide applications in northern ireland apple orchards due to miss-identification of a beneficial mite species. Res. J. Chem. Environ. 2004, 8, 77–78. [Google Scholar]
- Cuthbertson, A.; Audsley, N. Further screening of entomopathogenic fungi and nematodes as control agents for Drosophila suzukii. Insects 2016, 7, 24. [Google Scholar] [CrossRef] [PubMed]
- Khater, H.F. Ecosmart biorational insecticides: Alternative insect control strategies. In Insecticides—Advances in Integrated Pest Management; Perveen, F., Ed.; InTech: Pittsburgh, PA, USA, 2012; pp. 17–60. [Google Scholar]
- Aguilera Sammaritano, J.; Deymié, M.; Herrera, M.; Vazquez, F.; Cuthbertson, A.G.S.; López-Lastra, C.; Lechner, B. The entomopathogenic fungus, Metarhizium anisopliae for the European grapevine moth, Lobesia botrana Den. & Schiff. (Lepidoptera: Tortricidae) and its effect to the phytopathogenic fungus, Botrytis cinerea. Egypt. J. Biol. Pest Control 2018, 28, 83. [Google Scholar]
- Altimira, F.; De La Barra, N.; Godoy, P.; Roa, J.; Godoy, S.; Vitta, N.; Tapia, E. Lobesia botrana: A biological control approach with a biopesticide based on entomopathogenic fungi in the winter season in Chile. Insects 2021, 13, 8. [Google Scholar] [CrossRef]
- Wells, J.M.; Raju, B.C.; Hung, H.-Y.; Weisburg, W.G.; Mandelco-Paul, L.; Brenner, D.J. Xylella fastidiosa gen. nov., sp. nov: Gram-negative, xylem-limited, fastidious plant bacteria related to Xanthomonas spp. Int. J. Syst. Bacteriol. 1987, 37, 136–143. [Google Scholar] [CrossRef]
- European Food Safety Authority (EFSA). Update of the Xylella spp. host plant database—Systematic literature search up to 30 June 2019. EFSA J. 2020, 18, e06114. [Google Scholar]
- Luvisi, A.; Nicolì, F.; De Bellis, L. Sustainable management of plant quarantine pests: The case of Olive Quick Decline Syndrome. Sustainability 2017, 9, 659. [Google Scholar] [CrossRef]
- Saponari, M.; Boscia, D.; Nigro, F.; Martelli, G. Paolo Identification of DNA sequences related to Xylella fastidiosa in oleander, almond and olive trees exhibiting leaf scorch symptoms in Apulia (southern Italy). J. Plant Pathol. 2013, 95, 668. [Google Scholar]
- Greco, D.; Aprile, A.; De Bellis, L.; Luvisi, A. Diseases caused by Xylella fastidiosa in Prunus genus: An overview of the research on an increasingly widespread pathogen. Front. Plant Sci. 2021, 12, 712452. [Google Scholar] [CrossRef]
- Schaad, N.W.; Postnikova, E.; Lacy, G.; Fatmi, M.; Chang, C.-J. Xylella fastidiosa subspecies: X. fastidiosa subsp. piercei, subsp. nov., X. fastidiosa subsp. multiplex subsp. nov., and X. fastidiosa subsp. pauca subsp. nov. Syst. Appl. Microbiol. 2004, 27, 290–300. [Google Scholar] [CrossRef] [PubMed]
- Almeida, R.P.P.; Purcell, A.H. Homalodisca coagulata (Hemiptera, Cicadellidae) transmission of Xylella fastidiosa to almond. Plant Dis. 2003, 87, 1255–1259. [Google Scholar] [CrossRef]
- Cornara, D.; Bosco, D.; Fereres, A. Philaenus spumarius: When an old acquaintance becomes a new threat to European agriculture. J. Pest Sci. 2018, 91, 957–972. [Google Scholar] [CrossRef]
- Hill, B.L.; Purcell, A.H. Acquisition and retention of Xylella fastidiosa by an efficient vector, Graphocephala atropunctata. Phytopathology 1995, 85, 209–212. [Google Scholar] [CrossRef]
- Sengoda, V.G.; Shi, X.; Krugner, R.; Backus, E.A.; Lin, H. Targeted mutations in Xylella fastidiosa affect acquisition and retention by the glassy-winged sharpshooter, Homalodisca vitripennis (Hemiptera: Cicadellidae). J. Econ. Entomol. 2020, 113, 612–621. [Google Scholar] [CrossRef]
- Almeida, R.P.P.; Blua, M.J.; Lopes, J.R.S.; Purcell, A.H. Vector Transmission of Xylella fastidiosa: Applying fundamental knowledge to generate disease management strategies. Ann. Entomol. Soc. Am. 2005, 98, 775–786. [Google Scholar] [CrossRef]
- Chatterjee, S.; Almeida, R.P.P.; Lindow, S. Living in two worlds: The plant and insect lifestyles of Xylella fastidiosa. Annu. Rev. Phytopathol. 2008, 46, 243–271. [Google Scholar] [CrossRef]
- Purcell, A.H.; Frazier, N.W. Habitats and Dispersal of the Principal Leafhopper Vectors of Pierce’s Disease Bacterium in the San Joaquin Valley; Hilgardia: Berkeley, CA, USA, 1985; p. 32. [Google Scholar]
- Daane, K.M.; Wistrom, C.M.; Shapland, E.B.; Sisterson, M.S. Seasonal abundance of Draeculacephala minerva and other Xylella fastidiosa vectors in California almond orchards and vineyards. J. Econ. Entomol. 2011, 104, 367–374. [Google Scholar] [CrossRef]
- Janse, J.D.; Obradovic, A. Xylella fastidiosa: Its biology, diagnosis, control and risks. J. Plant Patol. 2010, 92, S1.35–S1.48. [Google Scholar]
- Cornara, D.; Morente, M.; Markheiser, A.; Bodino, N.; Tsai, C.-W.; Fereres, A.; Redak, R.A.; Perring, T.M.; Lopes, J.R.S. An overview on the worldwide vectors of Xylella fastidiosa. Entomol. Gen. 2019, 39, 157–181. [Google Scholar] [CrossRef]
- Redak, R.A.; Purcell, A.H.; Lopes, J.R.S.; Blua, M.J.; Mizell, R.F., III; Andersen, P.C. The biology of xylem fluid-feeding insect vectors of Xylella fastidiosa and their relation to disease epidemiology. Annu. Rev. Entomol. 2004, 49, 243–270. [Google Scholar] [CrossRef] [PubMed]
- EPPO Global Database Homalodisca vitripennis (HOMLTR). Available online: https://gd.eppo.int/taxon/HOMLTR (accessed on 31 August 2022).
- Giustolin, T.A.; Lopes, J.R.S.; Querino, R.B.; Cavichioli, R.R.; Zanol, K.; Azevedo Filho, W.S.; Mendes, M.A. Diversidade de Hemiptera Auchenorrhyncha em citros, café e fragmento de floresta nativa do Estado de São Paulo. Neotrop. Entomol. 2009, 38, 834–841. [Google Scholar] [CrossRef] [PubMed]
- Lago, C.; Garzo, E.; Moreno, A.; Barrios, L.; Martí-Campoy, A.; Rodríguez-Ballester, F.; Fereres, A. Flight performance and the factors affecting the flight behaviour of Philaenus spumarius the main vector of Xylella fastidiosa in Europe. Sci. Rep. 2021, 11, 17608. [Google Scholar] [CrossRef] [PubMed]
- Almeida, R.P.P. Xylella fastidiosa vector trasmission biology. In Vector-Mediated Transmission of Plant Pathogens; American Phytopathological Society Press: Saint Paul, MN, USA, 2016; pp. 165–174. [Google Scholar]
- Chatterjee, S.; Wistrom, C.; Lindow, S.E. A cell–cell signaling sensor is required for virulence and insect transmission of Xylella fastidiosa. Proc. Natl. Acad. Sci. USA 2008, 105, 2670–2675. [Google Scholar] [CrossRef]
- Killiny, N.; Almeida, R.P.P. Xylella fastidiosa afimbrial adhesins mediate cell transmission to plants by leafhopper vectors. Appl. Environ. Microbiol. 2009, 75, 521–528. [Google Scholar] [CrossRef]
- Killiny, N.; Almeida, R.P.P. Factors affecting the initial adhesion and retention of the plant pathogen Xylella fastidiosa in the foregut of an insect vector. Appl. Environ. Microbiol. 2014, 80, 420–426. [Google Scholar] [CrossRef]
- EPPO. PM 7/24 (4) Xylella Fastidiosa. EPPO Bull. 2019, 49, 175–227. [Google Scholar] [CrossRef]
- Serio, F.D.; Bodino, N.; Cavalieri, V.; Demichelis, S.; Carolo, M.D.; Dongiovanni, C.; Fumarola, G.; Gilioli, G.; Guerrieri, E.; Picciotti, U.; et al. Collection of data and information on biology and control of vectors of Xylella fastidiosa. EFSA Support. Publ. 2019, 16, 1628E. [Google Scholar] [CrossRef]
- Kikuchi, Y. Endosymbiotic bacteria in insects: Their diversity and culturability. Microbes Environ. 2009, 24, 195–204. [Google Scholar] [CrossRef]
- Margulis, L.; Fester, R. Symbiosis as a Source of Evolutionary Innovation: Speciation and Morphogenesis; MIT Press: Cambridge, MA, USA, 1991; p. 470. [Google Scholar]
- Gupta, A.; Nair, S. Dynamics of insect–microbiome interaction influence host and microbial symbiont. Front. Microbiol. 2020, 11, 1357. [Google Scholar] [CrossRef]
- Coolen, S.; Rogowska-van der Molen, M.; Welte, C.U. The secret life of insect-associated microbes and how they shape insect–plant interactions. FEMS Microbiol. Ecol. 2022, 98, fiac083. [Google Scholar] [CrossRef] [PubMed]
- Mazza, G.; Francardi, V.; Simoni, S.; Benvenuti, C.; Cervo, R.; Faleiro, J.R.; Llácer, E.; Longo, S.; Nannelli, R.; Tarasco, E.; et al. An overview on the natural enemies of Rhynchophorus palm weevils, with focus on R. ferrugineus. Biol. Control 2014, 77, 83–92. [Google Scholar] [CrossRef]
- Shaha, C.M.; Dar, M.A.; Pandit, R.S. Mining the diversity and functional profile of bacterial symbionts from the larvae of Chironomus circumdatus (Bloodworms). Folia Microbiol. 2022, 67, 861–872. [Google Scholar] [CrossRef] [PubMed]
- Siddiqui, J.A.; Khan, M.M.; Bamisile, B.S.; Hafeez, M.; Qasim, M.; Rasheed, M.T.; Rasheed, M.A.; Ahmad, S.; Shahid, M.I.; Xu, Y. Role of insect gut microbiota in pesticide degradation: A review. Front. Microbiol. 2022, 13, 870462. [Google Scholar] [CrossRef] [PubMed]
- Estes, A.M.; Hearn, D.J.; Bronstein, J.L.; Pierson, E.A. The olive fly endosymbiont, “Candidatus Erwinia dacicola”, switches from an intracellular existence to an extracellular existence during host insect development. Appl. Environ. Microbiol. 2009, 75, 7097–7106. [Google Scholar] [CrossRef]
- Janke, R.S.; Kaftan, F.; Niehs, S.P.; Scherlach, K.; Rodrigues, A.; Svatoš, A.; Hertweck, C.; Kaltenpoth, M.; Flórez, L.V. Bacterial ectosymbionts in cuticular organs chemically protect a beetle during molting stages. ISME J. 2022, 16, 2691–2701. [Google Scholar] [CrossRef]
- Harith-Fadzilah, N.; Haris-Hussain, M.; Abd Ghani, I.; Zakaria, A.; Amit, S.; Zainal, Z.; Azmi, W.A.; Jalinas, J.; Hassan, M. Physical and physiological monitoring on red palm weevil-infested oil palms. Insects 2020, 11, 407. [Google Scholar] [CrossRef]
- Almasoudi, N.M.; Asiry, K.A.; Abo-Elyousr, K.A.M. Isolation, identification and efficacy of three bacterial isolates against the red palm weevil, Rhynchophorus ferrugineus (Olivier) (Coleoptera: Curculionidae). Egypt. J. Biol. Pest Control 2022, 32, 52. [Google Scholar] [CrossRef]
- Butera, G.; Ferraro, C.; Colazza, S.; Alonzo, G.; Quatrini, P. The culturable bacterial community of frass produced by larvae of Rhynchophorus ferrugineus Olivier (Coleoptera: Curculionidae) in the Canary Island date palm: Frass bacteria from R. ferrugineus larvae. Lett. Appl. Microbiol. 2012, 54, 530–536. [Google Scholar] [CrossRef]
- Pu, Y.-C.; Xiang, H.-J.; Liang, X.-Y.; Wang, Y.; Hou, Y.-M.; Fu, L.; Wang, R. External immune inhibitory efficiency of external secretions and their metabolic profiling in red palm weevil, Rhynchophorus ferrugineus (Coleoptera: Curculionidae). Front. Physiol. 2020, 10, 1624. [Google Scholar] [CrossRef]
- Raio, A.; Roversi, P.F.; Francardi, V. Bacteria associated to Rhynchophorus ferrugineus (Olivier) (Coleoptera Dryophthoridae) in Italy. Redia 2016, 99, 53–57. [Google Scholar]
- Mahmoud, Y.A.; Salama, H.S.; Moawed, S.M.; Ebadah, I.M.A.; Sadek, H.E.; Khalifa, I.A. Virulence of a new isolate of Cytoplasmic Polyhedrosis Virus against the red palm weevil, Rhynchophorus ferrugineus (Oliv.) (order: Coleoptera, family: Curculionidae). Asian J. Agric. Hortic. Res. 2018, 2, 1–10. [Google Scholar] [CrossRef]
- Yasin, M.; Wakil, W.; Ghazanfar, M.U.; Qayyum, M.A.; Tahir, M.; Bedford, G.O. Virulence of entomopathogenic fungi Beauveria bassiana and Metarhizium anisopliae against red palm weevil, Rhynchophorus ferrugineus (Olivier): Virulence of fungi against red palm weevil. Entomol. Res. 2019, 49, 3–12. [Google Scholar] [CrossRef]
- Besse, S.; Crabos, L.; Panchaud, K. Efficacite de 2 souches de Beauveria bassiana sur le charançon rouge du palmier, Rhynchophorus ferrugineus. In Les Cochenilles: Ravageur Principal ou Secondaire 9ème Conférence Internationale Sur les Ravageurs en Agriculture; Association Française de Protection des Plantes (AFPP) Alfortville France: Montpellier, France, 2011; pp. 404–409. [Google Scholar]
- Lei, C.J.; Halim, N.A.; Asib, N.; Zakaria, A.; Azmi, W.A. Conidial emulsion formulation and thermal storability of Metarhizium anisopliae against red palm weevil, Rhynchophorus ferrugineus Olivier (Coleoptera: Dryophthoridae). Microorganisms 2022, 10, 1460. [Google Scholar] [CrossRef] [PubMed]
- Prashad, Y. A critical review of the bacteria Serratia marcescens and its impact on human health. WebmedCentral 2021, 10, WMC005573. [Google Scholar]
- Qin, S.; Xiao, W.; Zhou, C.; Pu, Q.; Deng, X.; Lan, L.; Liang, H.; Song, X.; Wu, M. Pseudomonas aeruginosa: Pathogenesis, virulence factors, antibiotic resistance, interaction with host, technology advances and emerging therapeutics. Signal Transduct. Target. Ther. 2022, 7, 199. [Google Scholar] [CrossRef]
- Tagliavia, M.; Messina, E.; Manachini, B.; Cappello, S.; Quatrini, P. The gut microbiota of larvae of Rhynchophorus ferrugineus Oliver (Coleoptera: Curculionidae). BMC Microbiol. 2014, 14, 136. [Google Scholar] [CrossRef]
- Islan, G.A.; Rodenak-Kladniew, B.; Noacco, N.; Duran, N.; Castro, G.R. Prodigiosin: A promising biomolecule with many potential biomedical applications. Bioengineered 2022, 13, 14227–14258. [Google Scholar] [CrossRef]
- Lim, S.; Bhak, J.; Jeon, S.; Mun, W.; Bhak, J.; Choi, S.Y.; Mitchell, R.J. The kiss of death: Serratia marcescens antibacterial activities against Staphylococcus aureus requires both de novo prodigiosin synthesis and direct contact. Microbiol. Spectr. 2022, 10, e00607-22. [Google Scholar] [CrossRef]
- Mai, A.-G.M. Serratia a novel source of secondary metabolites. Adv. Biotechnol. Microbiol. 2018, 11, 83–87. [Google Scholar] [CrossRef]
- Silva, C.R.; Miller, R.M.; Pereira, B.C.; Aveleda, L.; Marin, V.A. Genomic analysis and plant growth-promoting potential of a Serratia marcescens isolated from food. Res. Soc. Dev. 2022, 11, e29611124799. [Google Scholar] [CrossRef]
- Mozib, M.E.-F.; El-Shafie, H.A. Effect of red palm weevil, Rhynchophorus ferrugineus (Olivier) infestation on temperature profiles of date palm tree. J. Entomol. Nematol. 2013, 5, 77–83. [Google Scholar] [CrossRef]
- Muhammad, A.; Fang, Y.; Hou, Y.; Shi, Z. The gut entomotype of red palm weevil Rhynchophorus ferrugineus Olivier (Coleoptera: Dryophthoridae) and their effect on host nutrition metabolism. Front. Microbiol. 2017, 8, 2291. [Google Scholar] [CrossRef] [PubMed]
- Guilbeau, B.H. The origin and formation of the froth in spittle-insects. Am. Nat. 1908, 42, 783–798. [Google Scholar] [CrossRef]
- Whittaker, J.B. Cercopid spittle as a microhabitat. Oikos 1970, 21, 59–64. [Google Scholar] [CrossRef]
- Berlese, A. Gli Insetti: Loro Organizzazione, Sviluppo, Abitudini e Rapporti Coll’uomo; Società Editrice libraria: Milan, Italy, 1909; p. 1048. [Google Scholar]
- Šulc, K. Über Respiration, Tracheensystem und Schaumproduktion der Schaumcikadanlarven (Aphrophorinae Homoptera). Z. Für Wiss. Zool. 1911, 99, 147–188. [Google Scholar]
- Marshall, A.T. Batelli glands of cercopoid nymphs (Homoptera). Nature 1965, 205, 925. [Google Scholar] [CrossRef]
- Tonelli, M.; Cotta, S.R.; Rigotto, A.; Dias, A.C.F.; Andreote, F.D.; Bento, J.M.S. The composition of the bacterial community in the foam produced by Mahanarva fimbriolata is distinct from those at gut and soil. Braz. J. Microbiol. 2020, 51, 1151–1157. [Google Scholar] [CrossRef] [PubMed]
- Lahbib, N.; Picciotti, U.; Boukhris-Bouhachem, S.; Garganese, F.; Porcelli, F. Morphs of Philaenus species, candidate Xylella fastidiosa vectors. Bull. Insectology 2022, 75, 197–209. [Google Scholar]
- Beckett, K.I.S.; Robertson, A.B.; Matthews, P.G.D. Studies on gas exchange in the meadow spittlebug, Philaenus spumarius: The metabolic cost of feeding on, and living in, xylem sap. J. Exp. Biol. 2019, 222, jeb191973. [Google Scholar] [CrossRef] [PubMed]
- Ziegler, H.; Ziegler, I. Über die Zusammensetzung des Zikadenschaumes. Z. Für Vgl. Physiol. 1957, 40, 549–555. [Google Scholar] [CrossRef]
- Marshall, A.T. Protein synthesis and secretion by the Malpighian tubules of cercopoid larvae (Homoptera). J. Insect Physiol. 1973, 19, 2317–2326. [Google Scholar] [CrossRef]
- Mello, M.L.S.; Pimentel, E.R.; Yamada, A.T.; Storopoli-Neto, A. Composition and structure of the froth of the spittlebug, Deois sp. Insect Biochem. 1987, 17, 493–502. [Google Scholar] [CrossRef]
- Chen, X.; Meyer-Rochow, V.B.; Fereres, A.; Morente, M.; Liang, A.-P. The role of biofoam in shielding spittlebug nymphs (Insecta, Hemiptera, Cercopidae) against bright light: Biofoam shielding spittlebug nymphs against light. Ecol. Entomol. 2018, 43, 273–281. [Google Scholar] [CrossRef]
- Evtushenko, L.I.; Takeuchi, M. The family Microbacteriaceae. In The Prokaryotes; Dworkin, M., Falkow, S., Rosenberg, E., Schleifer, K.-H., Stackebrandt, E., Eds.; Springer: New York, NY, USA, 2006; pp. 1020–1098. [Google Scholar]
- Gómez-Gallego, C.; Rainio, M.J.; Collado, M.C.; Mantziari, A.; Salminen, S.; Saikkonen, K.; Helander, M. Glyphosate-based herbicide affects the composition of microbes associated with Colorado potato beetle (Leptinotarsa decemlineata). FEMS Microbiol. Lett. 2020, 367, fnaa050. [Google Scholar] [CrossRef]
- Rogowska-van der Molen, M.A.; Nagornîi, D.; Coolen, S.; de Graaf, R.M.; Berben, T.; van Alen, T.; Janssen, M.A.C.H.; Rutjes, F.P.J.T.; Jansen, R.S.; Welte, C.U. Insect gut isolate Pseudomonas sp. strain Nvir degrades the toxic plant metabolite nitropropionic acid. Appl. Environ. Microbiol. 2022, 88, e00719-22. [Google Scholar] [CrossRef]
- Jing, T.-Z.; Qi, F.-H.; Wang, Z.-Y. Most dominant roles of insect gut bacteria: Digestion, detoxification, or essential nutrient provision? Microbiome 2020, 8, 38. [Google Scholar] [CrossRef]
- Douglas, A.E. Multiorganismal insects: Diversity and function of resident microorganisms. Annu. Rev. Entomol. 2015, 60, 17–34. [Google Scholar] [CrossRef]
- Chevrette, M.G.; Carlson, C.M.; Ortega, H.E.; Thomas, C.; Ananiev, G.E.; Barns, K.J.; Book, A.J.; Cagnazzo, J.; Carlos, C.; Flanigan, W.; et al. The antimicrobial potential of Streptomyces from insect microbiomes. Nat. Commun. 2019, 10, 516. [Google Scholar] [CrossRef]
- Iembo, T.; da Silva, R.; Pagnocca, F.C.; Gomes, E. Production, characterization, and properties of b-glucosidase and b-xylosidase from a strain of Aureobasidium sp. Appl. Biochem. Microbiol. 2002, 38, 549. [Google Scholar] [CrossRef]
- Wang, P.; Jia, S.-L.; Liu, G.-L.; Chi, Z.; Chi, Z.-M. Aureobasidium spp. and their applications in biotechnology. Process Biochem. 2022, 116, 72–83. [Google Scholar] [CrossRef]
- Gilliam, M.; Prest, D.B.; Lorenz, B.J. Microbiology of pollen and bee bread: Taxonomy and enzymology of molds. Apidologie 1989, 20, 53–68. [Google Scholar] [CrossRef]
- Chen, L.; Chi, Z.; Liu, G.-L.; Xue, S.-J.; Wang, Z.-P.; Hu, Z.; Chi, Z.-M. Improved pullulan production by a mutant of Aureobasidium melanogenum TN3-1 from a natural honey and capsule shell preparation. Int. J. Biol. Macromol. 2019, 141, 268–277. [Google Scholar] [CrossRef] [PubMed]
- Zhang, M.; Gao, Z.-C.; Chi, Z.; Wang, Z.; Liu, G.-L.; Li, X.-F.; Hu, Z.; Chi, Z.-M. Massoia lactone displays strong antifungal property against many crop pathogens and its potential application. Microb. Ecol. 2022, 84, 376–390. [Google Scholar] [CrossRef] [PubMed]
- Lopes Martins, R.; Lobato Rodrigues, A.B.; de Menezes Rabelo, É.; Lima Santos, L.; Barreto Brandão, L.; Gomes Faustino, C.; Ferreira Farias, A.L.; da Cunha Sá, D.M.; de Castro Cantuária, P.; Kardec Ribeiro Galardo, A.; et al. Development of larvicide nanoemulsion from the essential oil of Aeollanthus suaveolens Mart. Ex Spreng against Aedes aegypti, and its toxicity in non-target organism. Arab. J. Chem. 2021, 14, 103148. [Google Scholar] [CrossRef]
- Clough, Y.; Ekroos, J.; Báldi, A.; Batáry, P.; Bommarco, R.; Gross, N.; Holzschuh, A.; Hopfenmüller, S.; Knop, E.; Kuussaari, M.; et al. Density of insect-pollinated grassland plants decreases with increasing surrounding land-use intensity. Ecol. Lett. 2014, 17, 1168–1177. [Google Scholar] [CrossRef] [PubMed]
- Hawkins, N.J.; Bass, C.; Dixon, A.; Neve, P. The evolutionary origins of pesticide resistance: The evolutionary origins of pesticide resistance. Biol. Rev. 2019, 94, 135–155. [Google Scholar] [CrossRef]
- Iqbal, M.; Jützeler, M.; França, S.C.; Wäckers, F.; Andreasson, E.; Stenberg, J.A. Bee-vectored Aureobasidium pullulans for biological control of gray mold in strawberry. Phytopathology 2022, 112, 232–237. [Google Scholar] [CrossRef]
- Hsu, C.-K.; Wang, D.-Y.; Wu, M.-C. A potential fungal probiotic Aureobasidium melanogenum CK-CsC for the western honey bee, Apis mellifera. J. Fungi 2021, 7, 508. [Google Scholar] [CrossRef]
- Di Francesco, A.; Di Foggia, M.; Corbetta, M.; Baldo, D.; Ratti, C.; Baraldi, E. Biocontrol activity and plant growth promotion exerted by Aureobasidium pullulans strains. J. Plant Growth Regul. 2021, 40, 1233–1244. [Google Scholar] [CrossRef]
- Iqbal, M.; Jamshaid, M.; Zahid, M.A.; Andreasson, E.; Vetukuri, R.R.; Stenberg, J.A. Biological control of strawberry crown rot, root rot and grey mould by the beneficial fungus Aureobasidium pullulans. BioControl 2021, 66, 535–545. [Google Scholar] [CrossRef]
- Zabkiewicz, J.A. Spray formulation efficacy–holistic and futuristic perspectives. Crop Prot. 2007, 26, 312–319. [Google Scholar] [CrossRef]
- Weiß, A.; Weißhaupt, S.; Hinze, M.; Leistra, P.; Kunz, S. Dispersal of Aureobasidium pullulans by pollinating insects to control Botrytis infection in strawberries. In Proceedings of the 15th International Conference on Oganic Fruit-Growing, Weinsberg, Germany, 22 February 2012; pp. 228–234. [Google Scholar]
- Schultz, T.R.; Gawne, R.; Peregrine, P.N. The Convergent Evolution of Agriculture in Humans and Insects; Vienna Series in Theoretical Biology; MIT Press: Cambridge, MA, USA, 2022; p. 327. [Google Scholar]

| Query Terms | Wolbachia | Buchnera | Rickettsia | Cardinium | Endosymbiont |
|---|---|---|---|---|---|
| Weevil | 33 | 1 | 34 | 2 | 56 |
| Rhynchophorus | 0 | 0 | 1 | 0 | 2 |
| Cosmopolites | 0 | 0 | 0 | 0 | 0 |
| Philaenus | 3 | 0 | 2 | 1 | 2 |
| Query Protein | Virus | Acc. n. | N. of Matches | Max id. (%) | Lowest E-Value |
|---|---|---|---|---|---|
| PIF-1 | Nilaparvata lugens endogenous nudivirus, isolate Hangzhou | KJ566575.1 | 87 | 60.0 | 0.002 |
| PIF-2 | Drosophila-associated nudivirus, isolate UA_Kan_16_57 | MT496843.1 | 100 | 60.0 | 0.001 |
| PIF-2 | N. lugens endogenous nudivirus, isolate Hangzhou | KJ566558.1 | 100 | 52.0 | 2 × 10−4 |
| PIF-2 | Hyposidra talaca nucleopolyhedrosis virus, isolate Hyta NPV-ID1 | MT642700.1 | 8 | 45.7 | 0.004 |
| PIF-2 (putative) | Macrobrachium nudivirus CN-SL2011 | JQ804993.1 | 100 | 65.0 | 1 × 10−4 |
| PIF-2 (mRNA) | D. melanogaster PFTAIRE | NM_169147.2 | 50 | 60.0 | 2 × 10−6 |
| PIF-3 (complete cds) | N. lugens endogenous nudivirus, isolate Hangzhou | KJ566581.1 | 67 | 81.8 | 0.001 |
| PIF-3 (putative, mRNA) | Cotesia congregata | FM201563.4 | 100 | 71.4 | 6 × 10−5 |
| PIF-4 | N. lugens endogenous nudivirus, isolate Hangzhou | KJ566551.1 | 26 | 60.0 | 0.001 |
| Product Records | 2022 | 2021 | 2020 | 2019 | 2018 |
|---|---|---|---|---|---|
| Insecticide | 705 | 71 | 53 | 50 | 51 |
| Microbiological insecticide | 238 | 44 | 42 | 18 | 23 |
| Biological Control Agent | 69 | 6 | 3 | 6 | 5 |
| Microbiological fungicide | 66 | 19 | 15 | 6 | 8 |
| Pheromone | 46 | 2 | 1 | 0 | 3 |
| Microbiological nematicide | 46 | 6 | 12 | 6 | 1 |
| Microbiological acaricide | 42 | 12 | 10 | 6 | 2 |
| Microbiological bactericide | 5 | 0 | 0 | 0 | 0 |
Disclaimer/Publisher’s Note: The statements, opinions and data contained in all publications are solely those of the individual author(s) and contributor(s) and not of MDPI and/or the editor(s). MDPI and/or the editor(s) disclaim responsibility for any injury to people or property resulting from any ideas, methods, instructions or products referred to in the content. |
© 2023 by the authors. Licensee MDPI, Basel, Switzerland. This article is an open access article distributed under the terms and conditions of the Creative Commons Attribution (CC BY) license (https://creativecommons.org/licenses/by/4.0/).
Share and Cite
Picciotti, U.; Araujo Dalbon, V.; Ciancio, A.; Colagiero, M.; Cozzi, G.; De Bellis, L.; Finetti-Sialer, M.M.; Greco, D.; Ippolito, A.; Lahbib, N.; et al. “Ectomosphere”: Insects and Microorganism Interactions. Microorganisms 2023, 11, 440. https://doi.org/10.3390/microorganisms11020440
Picciotti U, Araujo Dalbon V, Ciancio A, Colagiero M, Cozzi G, De Bellis L, Finetti-Sialer MM, Greco D, Ippolito A, Lahbib N, et al. “Ectomosphere”: Insects and Microorganism Interactions. Microorganisms. 2023; 11(2):440. https://doi.org/10.3390/microorganisms11020440
Chicago/Turabian StylePicciotti, Ugo, Viviane Araujo Dalbon, Aurelio Ciancio, Mariantonietta Colagiero, Giuseppe Cozzi, Luigi De Bellis, Mariella Matilde Finetti-Sialer, Davide Greco, Antonio Ippolito, Nada Lahbib, and et al. 2023. "“Ectomosphere”: Insects and Microorganism Interactions" Microorganisms 11, no. 2: 440. https://doi.org/10.3390/microorganisms11020440
APA StylePicciotti, U., Araujo Dalbon, V., Ciancio, A., Colagiero, M., Cozzi, G., De Bellis, L., Finetti-Sialer, M. M., Greco, D., Ippolito, A., Lahbib, N., Logrieco, A. F., López-Llorca, L. V., Lopez-Moya, F., Luvisi, A., Mincuzzi, A., Molina-Acevedo, J. P., Pazzani, C., Scortichini, M., Scrascia, M., ... Porcelli, F. (2023). “Ectomosphere”: Insects and Microorganism Interactions. Microorganisms, 11(2), 440. https://doi.org/10.3390/microorganisms11020440

